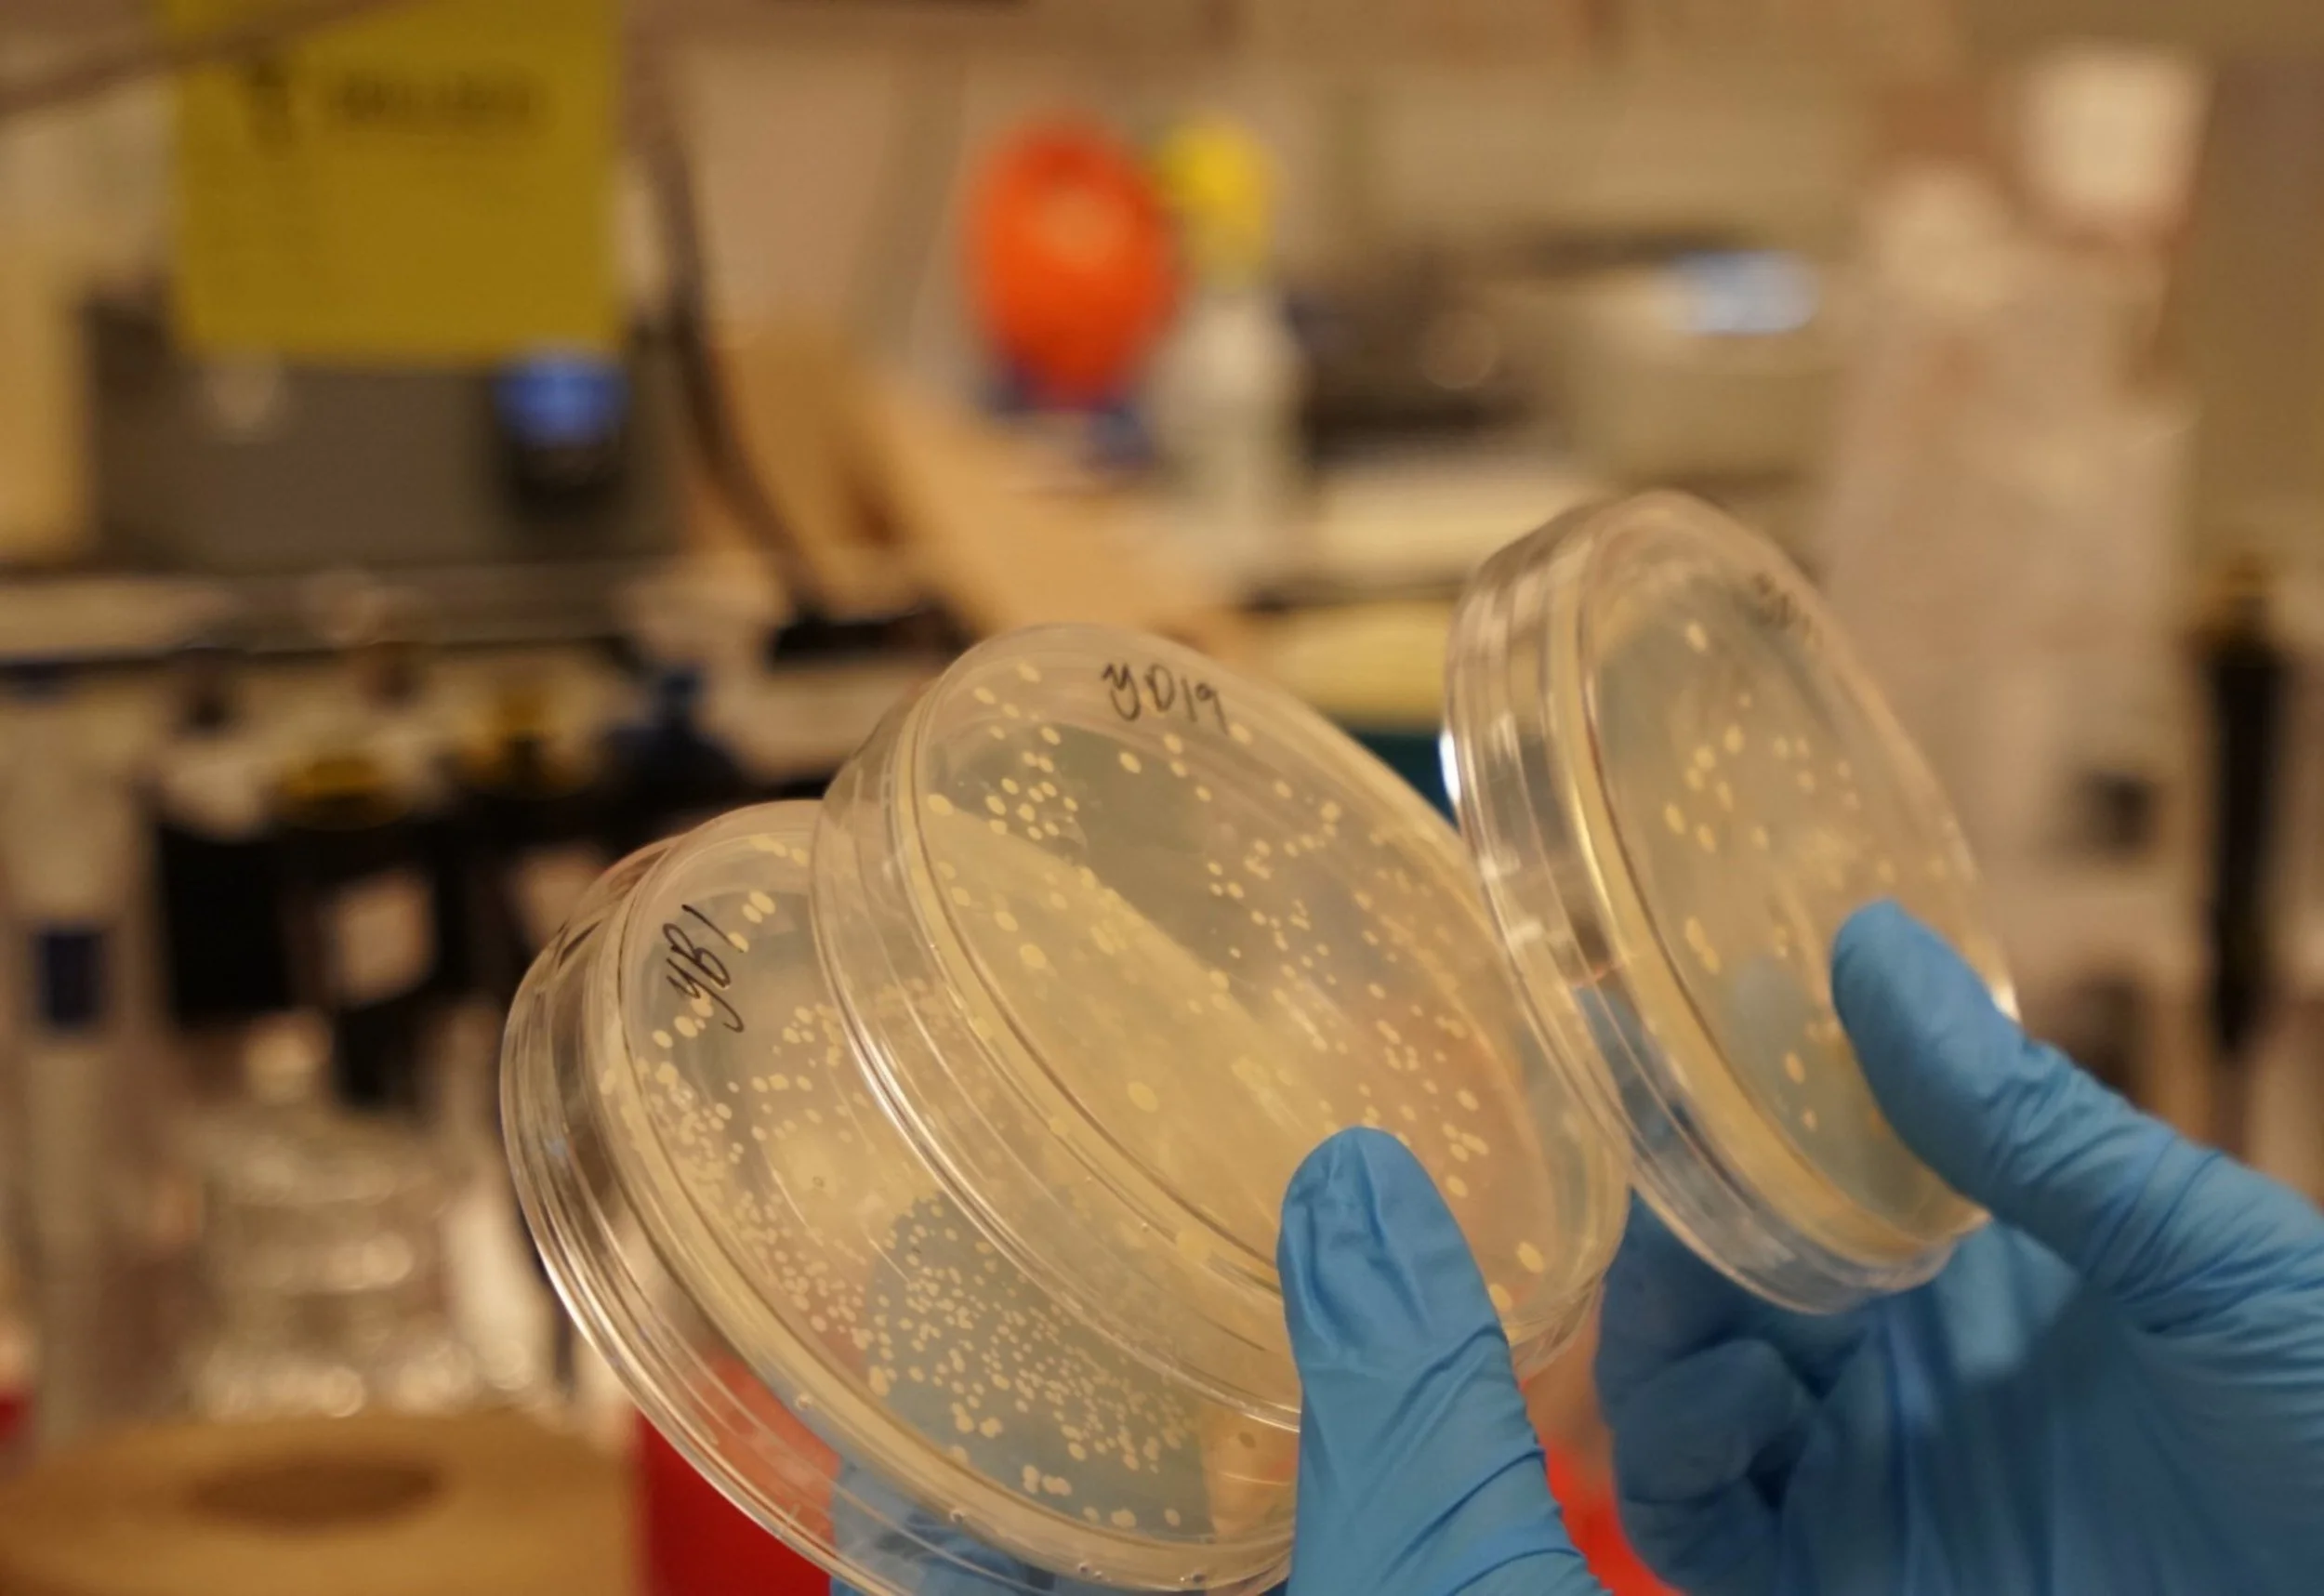
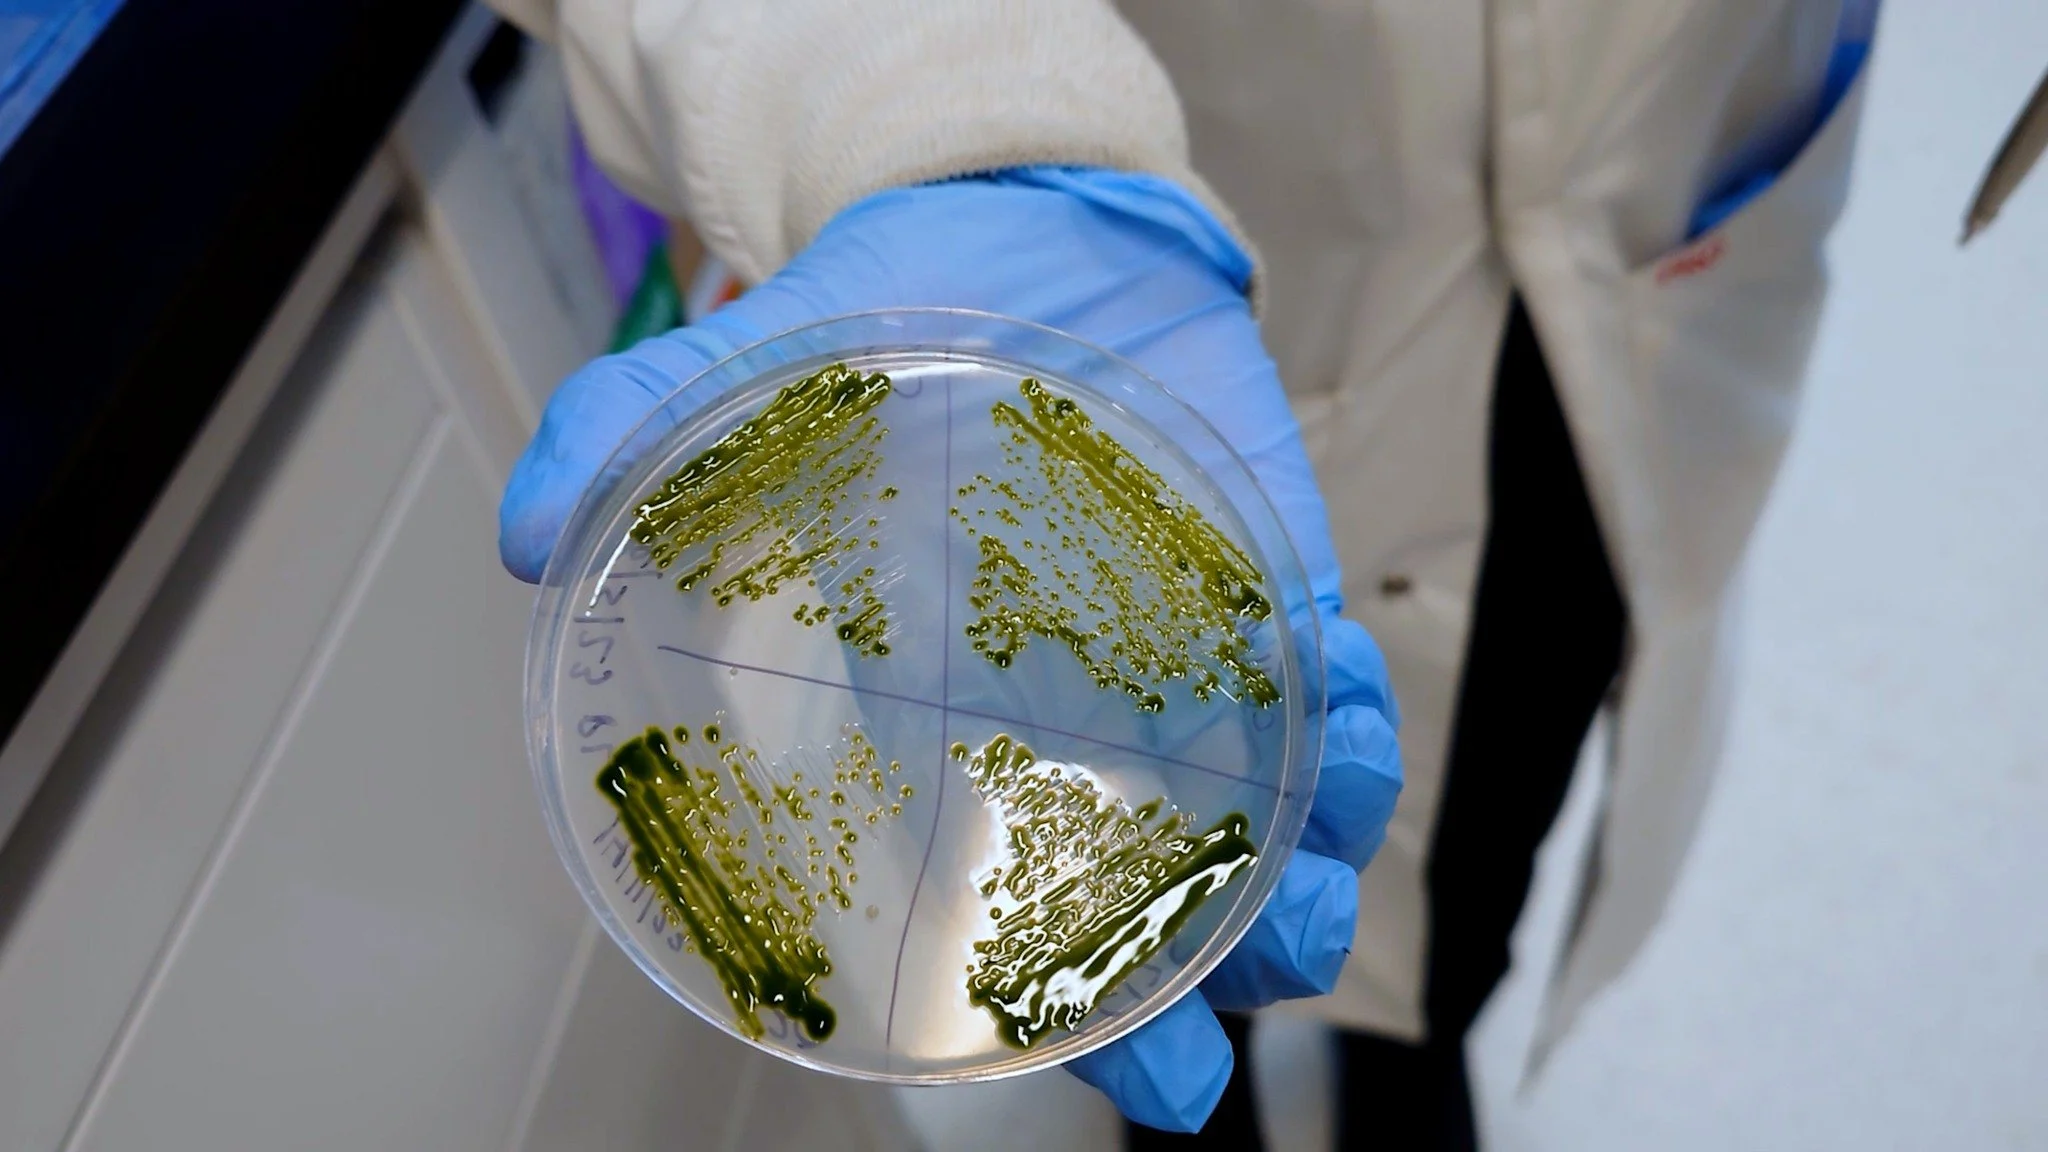
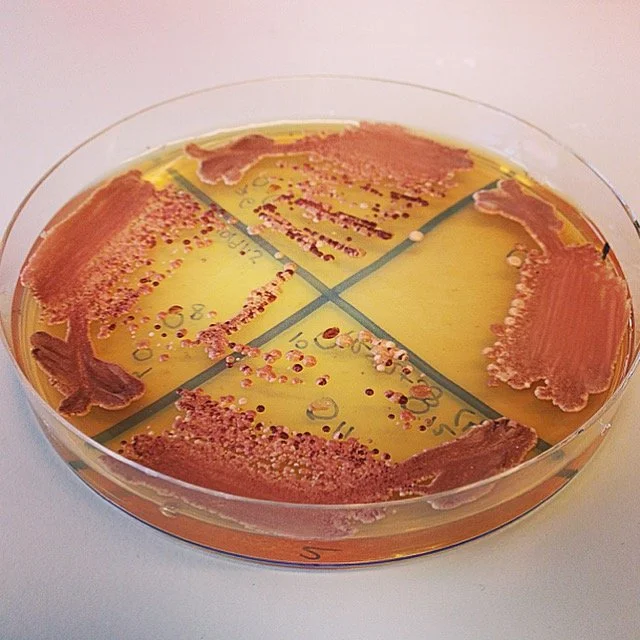

SynBio Canada: Turning Structure into Action
At our 2025 Annual General Meeting (AGM), directors and executives had a chance to summarize all of our accomplishments over the past year.
2025 Year in Review
At our 2025 Annual General Meeting (AGM), directors and executives had a chance to summarize all of our accomplishments over the past year, which are outlined here.
This past year marked a pivotal step in SynBio Canada’s maturation, building on its incorporation as a national non-profit. Focused primarily on operationalizing, SynBio Canada moved from a largely informal network to a more structured national organization, with active governance, formal financial systems, rebuilt leadership capacity, and the launch of funded programs. This shift positioned the organization to move toward sustained growth, delivery, and national impact. SynBio Canada is turning structure into action.
“It has been a great adventure working with this community so far and I’m excited to continue this into the new year!”
“I am honored to work with a dedicated board and committed to advancing our initiatives. We will continue to focus on strategic projects to enhance SynBio Canada’s impact on innovation and community building throughout Canada.”
Key Outcomes
Organizational Capacity: Rebuilt and expanded the executive team, elected a board of directors, and established core operational infrastructure to support growth.
Financial Foundation: Secured initial sponsorship funding from Flow Genomics and delivered the organization’s first funded programs.
Membership Growth: Total membership increased, with Canadian membership rising substantially and now representing over 80 percent of members nationwide.
Programs and Impact: Launched the Summer of SynBio Poster Competition, sponsored by Flow Genomics, providing direct financial and in-kind support to trainees and highlighting emerging Canadian research. See the winners from June, July, and August.
National Leadership: Initiated the “Made in Canada” discussion series, convened national discussions, and advanced policy-relevant publications to strengthen Canada’s synthetic biology and bioindustrial ecosystem.
Professional Development: Continued delivering high-value training through a workshop at SynBio 7.0 in Toronto, equipping trainees and professionals with transferable leadership and project-management skills.
“This year was a very exciting year for SynBio Canada, I am particularly proud of our collaboration with Flow Genomics and how we were able to directly support trainees in the community with the Summer of SynBio poster competition. Seeing the community involvement grow in just over a year has been really special, I look forward to building out more ways to directly engage with and celebrate our community over the next year. ”
“I’m so proud of what we’ve accomplished over the past year. There is so much enthusiasm for how synthetic biology can make a positive impact in Canada. This year in particular has helped focus this enthusiasm at a national scale.”
Board of Directors Re-Elected
SynBio Canada members re-elected the full slate of existing directors, reaffirming confidence in the strategic direction established in 2024. The renewed mandate provides continuity in leadership and enables the board to move from foundational work toward scaling programs, strengthening advocacy, and delivering greater value to members in the year ahead.
Looking Ahead
With core systems in place, SynBio Canada is positioned to expand funding, broaden programming, deepen regional engagement, and play a more influential role in shaping the future of synthetic biology and the bioeconomy in Canada.
“The inaugural year of the expanded SynBio Canada Board has been highly rewarding. I love where we landed on mission-vision; it’s grounded and compelling. I attended the second Internet World conference, back when Yahoo won new company of the year. This feels exactly the same. The most exciting outcome was the quality of the applicants to the Summer of Synbio contest; there is no greater evidence that Canada can lead the world with revolutionary ideas and products. ”
Announcing the last awardee of our National Summer of Synbio competition! Sponsored by Flow Genomics
Announcing the last awardee of our National Summer of Synbio competition! Sponsored by Flow Genomics
We're thrilled to announce our August winner of the nationwide Summer of SynBio Competition! Congratulations to Kathleen Hon, currently pursuing her Master’s in the Synthetic Biology Applications program at Concordia University!
Kathleen presented a compelling poster on engineering extracellular vesicles (EVs) in Saccharomyces cerevisiae, using high-throughput genetic tools to explore EV cargo loading for therapeutic applications. Her work showcases the potential of yeast as a platform for synthetic biology and was developed at Concordia’s Genome Foundry under the supervision of Dr. Christopher Brett.
Beyond the bench, Kathleen is a passionate advocate for science outreach. From founding the first SynBio Club at Western University to organizing community events like “SynBio Expressions,” she continues to champion the democratization of science through art, conversation, and education. Kathleen will receive $500 in cash and $500 in sequencing credits with Flow Genomics.
Special thanks to Flow Genomics for sponsoring this competition!
Announcing the awardee of July of our National Summer of Synbio competition! Sponsored by Flow Genomics
Synbio Canada announces its second awardee as part of the National Summer of Synbio competition! Sponsored by Flow Genomics
It is with great pleasure that we announce our awardee, Giselle McCallum currently doing her Ph.D. at University of British Columbia! Her project is titled Expanding the Bacteroides synthetic biology toolkit to develop an in vivo intestinal malabsorption biosensor. She is engineering Bacteroides thetaiotaomicron to serve as a biosensor for intestinal osmolality, enabling non-invasive, single-cell readouts of environmental changes in vivo. We loved how the information was communicated creatively through the graphics in the poster. The project was extremely interesting and we are looking forward to read the publication.
Flow Genomics provides fast, reliable and accurate sequencing services. They’ve sponsored this competition as enthusiastic supporters and valued members of Canada’s synthetic biology community.
This award is the second of three national prizes that will be awarded this summer. Synbio Canada is gathering applicants across the country to celebrate some of Canada’s synthetic biology achievements and enthusiasm. Giselle will receive the second of three prizes of $500 in cash and $500 in sequencing credits from Flow Genomics. Applications are open for one more award that will be announced in August.
Announcing the first awardee as part of our National Summer of Synbio competition! Sponsored by Flow Genomics
Synbio Canada announces its first awardee as part of the National Summer of Synbio competition! Sponsored by Flow Genomics
It is with great pleasure that we announce our first awardee, Victor Boddy from University of Ottawa! Victor’s project is part of this year’s UOttawa iGEM team. Their project, titled Arboguard, is focused on discovering new ways to repel mosquitos via the skin microbiome. We loved the creativity and enthusiasm in this project, as well as the well-organized poster and graphics. The ultimate potential of this project is to explore the possibilities of making a mosquito repellent that is longer lasting and less harmful to the environment.
Teams of undergraduates across Canada compete every year at the International Genetically Engineered Machine (iGEM) Competition for the past 21 years. Many of Canada’s professional and academic synthetic biologists got their first inspirations from participating in the iGEM competition. In addition to being outstanding opportunities for career development for undergraduates, there are many great examples of startups that have emerged from iGEM’ers, sometimes directly from the work they completed for the competition.
Flow Genomics provides fast, reliable and accurate sequencing services. They’ve sponsored this competition as enthusiastic supporters and valued members of Canada’s synthetic biology community.
This award is the first of three national prizes that will be awarded this summer. Synbio Canada is gathering applicants across the country to celebrate some of Canada’s synthetic biology achievements and enthusiasm. Victor will receive the first of three prizes of $500 in cash and $500 in sequencing credits from Flow Genomics. Applications are open for two more awards that will be announced in July and August.
Quick Chat: Dr. Codruta Ignea
By Emma Lindsay | November 22nd, 2024
Dr. Codruta Ignea is an Assistant Professor at McGill University in the Department of Bioengineering. She received her Bachelor of Science at King Michael I University of Life Sciences and her PhD in Protein Biotechnology at the University of Crete. Her research focuses on engineering simple organisms to create high-value compounds.
What inspired you to go into synthetic biology?
My background is in biotechnology. I figured out early on that I was interested in biology and chemistry, so I wanted a field where I could blend the two. I ended up specializing in microbial biotechnology during my undergraduate studies. Later, I pursued a master’s in natural products and biotechnology and went on to a PhD in protein biotechnology. By the time I finished my studies, synthetic biology was blooming. I started working in this field, combining it with my existing research in metabolic engineering.
Can you tell me about your research?
My research is focused on engineering microbial systems, specifically yeast, to produce bioactive compounds. I started by engineering the microbial chassis and various biosynthetic enzymes to yield different compounds of interest. I used a synthetic biology approach to engineer the biosynthetic pathway of carnosic acid, which is the main active compound in rosemary. From this we moved on to different compounds in the same family, using a similar synthetic biology approach. Our goal was to demonstrate how nature's existing biological parts can be recombined to create new biosynthetic pathways and systems that might not otherwise be possible. I was really successful with this research and managed to synthesize over 100 new-to-nature molecules. For instance, one of my recent successes involved producing terpene compounds with 11 carbon atoms, which is unusual. This was a significant breakthrough because 11-carbon compounds from this class of molecules are rare in nature. We’ve since gone even further, producing noncanonical compounds with up to 16 carbons that we’ve dubbed ‘Novoterpenes’.
What are the potential applications for these compounds?
Many of these compounds have biological activities, specifically in physiological defense or communication. The exciting thing is that we can apply these compounds beyond their original natural purposes. For example, carnosic acid, the compound I mentioned earlier, has strong antioxidant properties and is used in the food industry to prevent oxidation. Other compounds we’re developing have pharmaceutical potential. Take Taxol, for instance – it's a well-known anti-cancer drug that is actually a natural product. Some of these compounds are also being explored as food supplements, natural colorants, or biopesticides. The range of applications is quite broad. The new-to-nature molecules open some exciting possibilities for new applications, like developing unique drugs, creating innovative materials, or even using them in synthetic biology to build new pathways. There’s a lot of potential here, and I’m really excited to explore what we can do with these compounds!
Have you faced any challenges in engineering these pathways?
Absolutely, all the time. Challenges are part of the process, especially when working with bioactive compounds. Some of their biological activities are antibacterial or antifungal, and we often ask these microbes to produce compounds that are harmful to themselves. It’s pretty tricky. We are also working with yeast, which is quite robust and has an amazing adaptation system, so it finds ways to escape our engineering. Another challenge is the complexity of the pathways. It’s not as simple as combining a few enzymes and expecting everything to work perfectly. We have to deal with issues like enzyme regulation and system variability. Sometimes the activity of enzymes is suboptimal or different than expected, sometimes the organism produces the wrong compound. When engineering cells, there is high heterogeneity in these systems so you could have low-producing or high-producing colonies. With biopathways, you have successive steps where the product from one step becomes the substrate for the next, so conversion rates are very important, and you need large amounts of the early substrates to sustain extensive biosynthetic steps.
Are there any next steps in your research that you’re particularly excited about?
Yes! We’ve recently started collaborating on projects aimed at producing compounds that could help treat mental health conditions. I’m also excited about integrating artificial intelligence into synthetic biology. AI has the potential to help us navigate the enormous diversity of natural compounds much more efficiently. I believe AI will revolutionize not only synthetic biology but many other fields as well. It has the potential to accelerate research and open new doors that we haven’t even considered yet.
What advice would you give to young researchers or students interested in getting involved in synthetic biology?
This is my favourite question. I love working with students and I offered the first synthetic biology course at McGill. Synthetic biology is super exciting, and I can see that students love synthetic biology too. My advice would be to embrace interdisciplinarity. Synthetic biology is not a single discipline—it combines biology, chemistry, engineering, computer science, and more, and it’s evolving very quickly. Students should build skills in both wet lab and dry lab, as both are essential in this field. And finally, always consider the ethical implications of your work. It’s important to think critically about the impact our research will have on society.
Dr. Codruta Ignea’s Lab members at McGill University
Dr. Ignea’s work on engineering biosystems and producing high-value compounds has a wide range of applications, changing the face of pharmaceuticals and food science. She highlights the importance of learning interdisciplinary skills and utilizing tools to maximize the discovery of new-to-nature molecules.
Quick Chat with Julie Legault
By Emma Lindsay - SEPTEMBER 30th, 2024
Julie Legault is the founder of Amino Labs. She earned her Bachelor of Fine Arts in Design and Computation Art, and her Graduate Certificate in Digital Technologies in Design Art Practice at Concordia University. Julie went on to earn her Master of Art at the Royal College of Art and a Master of Science at the Massachusetts Institute of Technology (MIT) Media Lab. Her interest in learning synthetic biology and genetic engineering inspired her to found Amino Labs, whose goal is to make biotechnology and synthetic biology more accessible to the next generation.
What inspired you to shift your focus from design to biotechnology and SynBio?
I first got involved in synthetic biology in 2014 while studying at MIT. I attended a workshop on synthetic biology out of curiosity, not knowing much about it, and being enticed by the free breakfast. During the workshop, we built a DNA plasmid that produces violacein, a compound used in research that is this beautiful purple colour, and put it in bacteria. This was my first experience working with a pipette, and it was exciting to see the process. Also, the workshop took place in a kitchen rather than a typical lab setting.
As I began to understand synthetic biology better, it provided me with context for concepts like GMOs and CRISPR, which are often discussed in the news but not explained. I was really excited and wanted to keep experimenting with the bacteria and the colours. I got some lab space at MIT to continue experimenting. I was not trained to work in labs, and I found it difficult to understand what I was supposed to do. I kept calling the scientist over for help with where to find supplies and how to do different things. I realized this one experiment in the kitchen had changed my attitude and understanding of science.
I decided to create a mini-lab for myself. With my background in product design, I was familiar with 3D printers and laser cutters, so I set up a small lab with essential equipment like a centrifuge and an incubator. This led to the start of Amino Labs, which is our company.
At Amino Labs, we focus on helping science teachers and learners at home conduct their first experiments in synthetic biology. We provide tools and pre-measured kits so that users don’t need access to a full lab. This approach is beneficial for beginners and teachers who may lack the time, resources, or expertise to set up and execute experiments on their own.
How did the opportunity to collaborate with Dr. Justin Pahara arise?
Dr. Pahara was the one who led the workshop I attended at MIT. He came with his first company, Synbiota, and did the biohackathon. He was the scientist I frequently reached out to for help. He agreed to advise on my thesis, which involved the lab I had built. After graduating, MIT offered some funding to continue developing the lab and explore its potential as a company. I brought Dr. Pahara on as an advisor, and when his company, Synbiota, eventually wound down, it was a smooth transition to bring him on as a co-founder.
It was a combination of luck of circumstances and necessity. You can't have a science company without a scientist, and Dr. Pahara was very supportive. Unlike some scientists who believe you need formal training to do science, he was enthusiastic about DIY biology and encouraged my efforts. His openness and belief in the company’s mission made him a great match.
What were the biggest challenges you faced in turning your idea into a functional tool for beginners?
During the development of my prototype, one of the biggest challenges was overcoming skepticism from scientists. People doubted whether a tiny incubator should be used by children. We specifically target users above the age of 12, since younger kids may lack the dexterity required and might ingest things they shouldn’t.
Another significant barrier was the cost of educational materials. In Canada, we’re a bit luckier because schools generally have better budgets compared to the US or other countries, but some teachers still have to pay out of pocket for experiments. We needed to address this issue by making our experiments as cost-effective as possible. We developed methods to conduct experiments without expensive equipment like incubators or pipettes. By removing these costs, we allowed students to perform basic experiments, such as streaking a Petri dish, even on a tight budget. This approach helps schools get started with hands-on science and provides a foundation for further investment in the future.
Are there any upcoming products or initiatives at Amino Labs that you’re particularly excited about?
We’re currently celebrating our 9th anniversary this week, which is really exciting! One of our latest projects is an animation that celebrates the journey of a student learning science. We're working on promoting it and getting it out there.
In the longer term, we’re looking to expand our experiments to include biomanufacturing. Most of our current experiments are based on bacteria, but we’ve already developed a couple related to biomanufacturing and plan to push more into this area. We have a book that goes along with our bacterial experiments, and we’re hoping to also create a similar book for biomanufacturing.
For anyone interested in getting their teachers or schools involved, there are opportunities to do so. In Alberta, for example, we collaborate with a nonprofit organization that provides some of our resources to classrooms at no cost, helping to relieve the financial burden on schools. Additionally, we offer a range of free resources that can be utilized. Schools in the US are taking up synthetic biology more rapidly than schools in Canada. It would be great if fellow scientists could get their local schools involved.
What specific skills or concepts do you hope students take away from using the experiment kits?
I want to show kids that science is not scary, and it’s not exclusive for certain people. Anyone can engage with science, whether it's pursuing a career in it or simply understanding it. This knowledge is valuable when making informed decisions about things like vaccines, genetic testing, or emerging gene therapies. It’s important for people to understand these topics and not take everything at face value. In today's world, where there’s increasing mistrust in science, it's important to help students and children understand that science is not evil.
What advice do you have for someone who is interested in starting their own company or dipping into a new field?
If you’re entering a new field, find people who are receptive to your plans and ideas. Try to collaborate with them, or at least have discussions with them. It can be challenging to navigate on your own without any support or contacts, so making connections within the community, whether online or in person, is very beneficial.
If you’re starting a company, the advice is the same. Having a strong support network is essential. Surround yourself with people who will support you through the ups and downs, whether they are co-founders, teammates, or friends. There will be challenging moments, and having supportive people around can make a significant difference. It doesn’t require a massive network or high-profile connections. Even having a few supportive individuals who can provide advice or point you in the right direction can be incredibly helpful.
Julie Legault’s transition from design to synthetic biology has introduced an affordable, hands-on opportunity for students and beginners to explore synthetic biology. With Amino Labs, Julie has created tools to make science more accessible to the public.
Quick Chat with Prof. Isabel Desgané-Penix
By Emma Lindsay - June 20th, 2024
Dr. Isabel Desgagné-Penix is a professor in the Department of Chemistry, Biochemistry, and Physics at the University of Québec at Trois-Rivières (UQTR). She completed her PhD in Cell and Molecular Biology at the University of Texas at San Antonio and her post-doc in plant biochemistry and metabolism at the University of Calgary. Her research uses synthetic biology to construct and analyze plant metabolic pathways in microalgae to produce phytomolecules.
Can you tell me about yourself and your research?
I have been a professor for a little bit over 10 years, specializing in metabolic engineering. In synthetic biology, I am an end user, using a synthetic biology platform to produce specialized metabolites of interest or validate the pathways of plant specialized metabolism. We use microalgae, specifically the green microalgae Chlamydomonas reinhardtii and the diatom Phaeodactylum tricornutum. These are among the few microalgae for which we have tools in synthetic biology. In the green algae, we insert DNA into the nuclear genome, while in diatoms we can either insert it into the nuclear genome as well or we can keep it episomal and introduce large fragments using bacterial conjugation. When we are introducing a full metabolic pathway with many steps, we use a large amount of DNA, and we prefer to keep it extrachromosomal. As we use these tools and technology advances, we realize there is still a lot to learn about our systems to effectively use them in synthetic biology. That is what's great about it, as we try things, we discover new processes.
Why did you choose to use microalgae as a model for your research?
When I started 10 years ago, I had done a postdoc working on systems biology to elucidate pathways that were used for synthetic biology in yeast. I was super interested in that. Although my expertise is in plant specialized metabolism, I also wanted to use synthetic biology to validate the pathways and produce compounds of interest. In yeast, you have a lot of tools but also many challenges. Often, the pathways I'm interested in, involve different compartments like the chloroplast and the vacuole, which in yeast they don’t necessarily exist or need to be created. Creating yeast platforms is not my expertise, so I thought why not use a single cell microalgae platform? That is why we chose microalgae, because it is an eukaryotic organism and can perform all the post-translational modifications that the enzymes need. It also contains all the compartments needed to build a very complex plant metabolic pathway. Another reason for choosing microalgae is my commitment to making a better future, being conscious of carbon emissions and sustainable production. Microalgae offers this advantage, as they can detoxify the air and don’t require large sugar or carbon sources except cardon dioxide. That makes it a very interesting production platform.
What inspired you to work with plant metabolism and phytomolecules?
This was a long time ago when I was a little girl. Women in my community used to prepare these remedies using roots or leaves for various ailments. I was fascinated by this, and I always loved science, wondering what was in these grandmother remedies. This curiosity led me to the world of biochemistry. I wanted to go into medicine, but I was not accepted, so I chose immunology and microbiology instead, completing my master’s and PhD. During my PhD, I worked with an amazing professor that specialized in plant metabolism. Her enthusiasm reignited my interest in plants and plant molecules. Her interest was contagious. I realized I could combine science with working on medicinal plants and I thought that was so great. When I became a professor, I really wanted to continue with that.
What techniques are you using to study and manipulate plant metabolic pathways in microalgae?
Chlamydomonas reinhardtii transformed strain.
Any molecular biology technique used in metabolic engineering and synthetic biology in bacteria or yeast you can use in microalgae. We often try to screen or clone like you would in yeast, but we tag it with a fluorescent protein and use flow cytometry or fluorescent microscopy to identify positive transformants. We use a lot of biochemistry and have an advanced analytical platform, including mass spectrometry and NMR, to determine whether the microalgae produce the desired compound, because microalgae might perform unexpected reactions. For instance, we recently published research on producing cannabinoids in microalgae. We were successful in producing cannabinoid precursors and some cannabinoids, but we also detected other compounds that look like cannabinoids but are not known to nature. We were also working with a company wanting to produce specific THC or CBD molecules so we have analytical platforms that can detect these molecules. Our lab employs various techniques, including biochemistry, mass spectrometry, organic chemistry, and bioinformatics. Some students also work on medical biology projects, such as testing for antivirals or antimicrobials from various medicinal plants.
Can you discuss potential industrial applications of your research?
We have been working with industrial partners to produce specific molecules they need such as cannabinoids, pharmaceutical compounds, or antiviral compounds. I hope our platform will be viable for producing very complex compounds. For instance, one of them is used to treat the symptoms of Alzheimer’s disease. Our goal is to have it commercialized and ensure its produced sustainably.
You have your lab and your team, what do you look for in your students when you're recruiting people to your team?
Of course, they need to be independent, capable of taking guidelines, deciding the next steps, and thinking ahead. They should be genuinely interested in their work, with their enthusiasm being contagious. I want my students to be self-motivated in their research. It is important they understand how the lab operates and have a solid grasp of molecular biology and biochemistry. In my lab, we believe in the Equity, Diversity and Inclusion principles such as woman are equal, gender exists on a spectrum, black lives matter, Idle no more, etc. It is important that my students are sensitive to these issues and live by them. Everyone has a place in the lab and everyone should feel comfortable regardless of their background, identity, culture, religion, or goals. We also prioritize environmental protection. For example, we have a machine to wash and reuse our tips, which is a lot of work for the team members but helps reduce plastic usage. I believe in these principles and I want the people in my lab to be just as committed.
What have you found to be the biggest obstacle in studying the metabolic pathways in microalgae?
There are many unknowns, and sometimes we lack the steps needed to understand certain processes. Unknown chemical reactions, especially complex ones, are particularly challenging. Epigenetics and silencing also. However, it is very rewarding when we can elucidate these steps.
What advice would you give to young researchers who are aspiring to enter the field of synthetic biology?
I know they have these iGEM competitions and various scholarships. Before getting involved and joining a lab, it is a good idea to know what you want to achieve and what you want to do. Research and inform yourself about which lab you could join, so you are not surprised when you arrive. For example, students who come to my lab may not do as much synthetic biology as they would in a lab that works with yeast and bacteria. It is important to be informed about where you are going and what you will be working on. Sometimes students do not always have this liberty, but if given the choice, go to a place that aligns with what you want to do.
How do you think synthetic biology will impact the future?
Synthetic biology is very important for the future, although I am biased. It is a new flavour/colour of science. It could help with a lot of issues that the world has today, whether it is pollution, medicine, agriculture, or even societal issues. It spans from fundamental research to various applications and commercialization's. Everybody can have a place in synthetic biology.
Dr. Isabel Desgagné-Penix's research in plant specialized metabolism using microalgae advances the synthesis of valuable phytomolecules. Her inclusive lab environment prioritizes sustainability and is dedicated to furthering synthetic biology for a better future.
Quick Chat with David Stuart
By Emma Lindsay - 26th MAY 2024
Dr. David Stuart is a Professor and Graduate Coordinator at the University of Alberta in the Department of Biochemistry. His research focuses on the application of synthetic biology on the metabolic engineering of yeast and bacteria to produce biofuels.
Can you tell me about yourself and your research?
I did my PhD at the University of Alberta, and I did Postdoctoral work at The Scripps Research Institute, where I focused mostly on cell cycle control and yeast as a model. My PhD work I would say started my synthetic biology interest. I was building synthetic chromosomes for a pox virus to analyze its DNA replication and how its chromosomes were prepared for packaging. I got training in yeast genetics at Scripps Research Institute with Curt Wittenberg and Steve Reeds labs. I started my position here at University of Alberta initially working on cell cycle control and meiosis. Around 2010 there was a small group here that was interested in engineering yeast to generate biofuels. Not ethanol, but something more nonconventional. We got into the butanol space and started constructing strains to synthesize butanol and isobutanol. That required multi gene pseudo-operons to be constructed and introduced into yeast to synthesize the 4-carbon alcohol butanol. At that point, I got most interested in manipulating biology to create and solve problems and doing more applied research. A little bit less of the basic science side and more on the applied science side.
Was there anything specific that inspired you to go into biofuels?
I had some push from my children who recognized and had concern about environmental problems. Producing and burning petroleum liquid transport fuel at the scale that we currently do has a significant impact on our environment. I got intrigued with the potential benefits of a circular system that could use rapidly renewable carbohydrate feed-stock to be converted by yeast or bacteria into a viable transport fuel like butanol or isobutanol. Building a new metabolic pathway into cells and coaxing them to make a product that is not natural to them is a challenging but fun puzzle. Increasing the uptake of biofuels with a lower impact on the environment than petroleum products is not going to be the whole answer to our challenges, but it can be part of the answer. Another piece of this that I like is the idea that biofuel production can be a distributive thing rather than having all your fuel coming from one refinery. We can take the approach of having lots of little distributive hubs that can make whatever you want on smaller scales, but sufficient for the area. It’s economically beneficial and you don't have to move your feedstock from one end of the world to the other end to make something.
We progressed from engineering cells to produce short chain alcohols like butanol to making longer chain fatty alcohols. These are not used as fuel but are widely used in everything from food to shampoo, soaps, hair conditioners and cleaning agents. Most of the global supply of these chemicals is either synthesized from ethylene, a petroleum by product or from palm oil. Although palm oil is a renewable source expanding palm oil plantations have resulted in extensive deforestation and loss of biodiversity. It got me thinking that maybe we can engineer yeast to produce these products on demand in fermenters rather than displacing rain forest. Synthesizing the product with engineered yeast close to the end user industries also reduces the carbon footprint from shipping the raw material or products between continents.
What are some obstacles you’ve had to face in your Synbio career?
Technical issues, for some things there seems to be no way to get them work as well as you would like them to. Things like titres of final products, for example the fatty alcohols. We can engineer yeast to make and secrete them, but there are limits to productivity. So those are technical things that can be very difficult. Sometimes finding funding for projects is difficult too.
Do you have any sort of memorable achievements or experiences in your career so far?
Going back to the fatty alcohols project, I think the first time that we saw that the yeast we were working with, not only made the product, but secreted the product. One of the Postdocs, Bonnie McNeil, brought me this tube with all this gooey stuff floating on the top. The cells had made that, secreted it out, and it floated up to the top. And wow is that ever cool. So that was that was quite memorable, that was a big one for me.
What does a typical day look like for you?
Most days I swim with a master swim team in the morning, I feed my rabbits, and go to the lab. In the Biochemistry department at University of Alberta I wear several hats. My laboratory has three graduate students, four undergraduate students, and we have an intern from Peru here right now. I supervise people in the lab, and I occasionally do an experiment myself. Not that often anymore. My office is in the laboratory space, so I'm with the people in the lab a lot of the time. I'm also the graduate program director, so I deal with everything around graduate students and their programs, making sure people complete their theses and stuff like that. At different times of the of the year I have significant teaching loads. Right now, I teach a course on proteomics in the morning, and then a discussion group in the afternoon on molecular biology. I teach some classes, work with people in the lab and collaborators, have a few meetings around the graduate program, and that’s my day.
Are there any synthetic biology techniques or applications you’re excited about?
I'm very excited about the improved effectiveness and accuracy of Cas9-based prime editors for genome engineering. This just keeps getting better and has very wide-ranging potential. As far as applications, I think engineered probiotics are going to become a big thing. These have potential to identify and kill pathogens so can act as antimicrobials. They can also be used to secrete beneficial small molecules and metabolites or metabolize toxic or otherwise harmful metabolites and small molecules. There is potential for them to act as therapeutics for delivering cancer treatments or treat inborn errors of metabolism. I like the idea that these can act as little factories that can be set up to operate inside of us to deliver therapeutic molecules at the site of the infection or pathology. There’s a lot of possibilities that might not be immediately obvious, the lung microbiome for example. We could have engineered microbial cells that help support surfactants in the lung space or that degrade biofilms created by pathogens. In the colon, the bladder or on the skin engineered bacteria could specifically detect and kill pathogens, degrade toxic molecules or secrete beneficial ones. These could treat diseases as well as influence health or even your psychological state. I think that's a place that there's going to have a lot of impact. I'm also pretty excited about advances in cellular agriculture, although that is still pretty expensive as an application, and the potential to produce food protein and even milk with fungi or other microbial cells. Fungal protein is a lot easier in some respects and cheaper. It doesn't require a lot of the infrastructure that's necessary for lab grown meat. That could influence problems like food security, for example.
Where do you see your research going in the next five years?
I'm still working on bio-industrial problems related to production of fatty alcohols and lipid-based compounds to some extent, but it's moved a little bit more to the biomedical sector. My own research is heading more towards the engineered probiotics that can act as biosensors and provide specific benefits to humans and agricultural animals. I am currently very interested in appropriating enzymes from bacteriophages and using them to weaponize probiotic yeasts so that they can specifically identify and kill infectious pathogens. Related to this, I am investigating new ways to use nanobodies as antimicrobial agents.
What advice do you have for students interested in pursuing a career in synthetic biology?
I really like the broad definition of synthetic biology as engineering cells to make useful things or do cool stuff. There are a growing number of opportunities both academic and industrial for people who want to make this a career. This is a field that thrives on creativity, interdisciplinarity, and collaborative skills so those are characteristics that you should develop and nurture. Pay attention to the world around you and you will recognize that there are problems big and small, local and global that can be tackled. Synthetic biology has a big toolbox, it is more than just microbiology and molecular biology at the lab bench. Skills in software engineering, process engineering, bioinformatics, automation, business development, and more are involved so you can come to this from many different disciplines. A great place to get started is iGEM. I supervise an iGEM team here at the University of Alberta, it's a great place to get started because there's a lot of resources, and the competition aspect is highly motivating to get people thinking about problems that can be solved by engineering biology. In these groups, you can also see how an interdisciplinary team can be assembled with people who know how to manipulate DNA and microbial organisms, and integrate that with process engineering, bioinformatics, public outreach, even business development. The biggest thing is just having an open mind, being creative and being able to recognize needs. There are problems that we can solve, and it's not hard to find places to get involved.
Dr. David Stuart’s research spanning from yeast genetics and cell cycle control to biofuel production highlights the importance of synthetic biology applications in developing environmental crisis solutions. His work in addressing health and environmental challenges also inspires future scientists to pursue innovative solutions.
Quick Chat with Professor Sébastien Rodrigue
By Emma Lindsay - APRIL 18TH 2024
Dr. Sébastien Rodrigue is a professor at the Université de Sherbrooke in the Department of Biology. His research focuses on microbial systems, synthetic biology, and genomics to understand microbial genomes and develop methods to modify them. He is also the Co-Founder of TATUM Bioscience, a therapeutic company that uses synthetic biology to develop immunotherapies.
Can you tell us about yourself and your research?
I did my BSc and PhD in the Département de Biologie at the Université de Sherbrooke. During my thesis, I was interested in understanding the full genetic program of a bacterium using Mycobacterium tuberculosis as a model. I considered cells as “living robots” that could eventually be programmed to yield better vaccines or new therapies. However, M. tuberculosis was already a complex and specialized pathogen, which directed me to search for simpler model systems that would be easier to fully grasp. This led me to start a postdoc at the Massachusetts Institute of Technology where I studied Prochlorococcus, a very abundant marine cyanobacterium with a small genome and very few transcription regulators that could potentially be hacked for biotechnological applications. Prochlorococcus was fascinating but proved to be much more difficult than I anticipated for different reasons. I developed a collaboration with Tom Knight as a side project and started working on Mesoplasma florum, which is a mycoplasma-like bacterium with an even smaller and even simpler genome of about 800kb and 685 genes. I was recruited back at the Université de Sherbrooke and decided to focus my lab on minimal genomes and synthetic genomics. Since then, my group uses M. florum but also E. coli to develop new tools and therapeutic approaches using synthetic biology.
Why did you decide to use Mesoplasma florum as a model? What made it easier to work with?
M. florum has one of the simplest genomes while also growing fast with a doubling of approximately 30 minutes. In contrast to other small genome mycoplasma, M. florum is an insect commensal that has no known pathogenic potential. It is also easy to get colonies on agar plates, which sounds straightforward, but for some bacteria like Prochlorococcus can be difficult. Overall, it was a fast-growing organism, with a small genome and a good potential to do interesting synthetic genomics projects.
What inspired you to go into synthetic biology?
I think it was the vision that cells are machines, and that if we understand them enough, we could reprogram and engineer them for various applications. I like to say synthetic biology is like studying a putative alien technology: if we had a UFO to dismantle and play with the parts, we could potentially understand it sufficiently to rebuild a flying machine or even create new technologies.
Your work consists of modifying the genomes of organisms; do you think the public has a good understanding of its applications?
No, I don’t think the public knows or understands exactly what synthetic biology is about. This can raise concerns, especially in the post-COVID era. It would be important to explain the goals of synthetic biology, the potential benefits, and the intense work on biocontainment mechanisms to ensure safety. This will be particularly important if we want to build new therapies that can treat and cure patients without any additional risk of infection. I think there will be a lot of innovation in that area in the coming years.
Where do you envision the field of synthetic biology being in the next five years?
I think we are just starting to see the true potential of synthetic biology. Most circuits that we build right now only have a few genes. This is enough for many applications, but in my opinion, we will slowly move towards more complex circuits, and synthetic genomes that offer interesting properties such as ease of engineering, modularity, genetic insulation, and resistance to viruses. I also hope it will become much cheaper to write DNA since this remains an obstacle for many projects and that we will see more real-world applications in addition to fundamental advances.
Your research can be applied to a wide range of applications such as medicine and the environment, where do you think your research will have the greatest impact?
I think at first, it will be in the medical world. Biology had most of its notorious achievements in medicine, and it is probably easier for synthetic biology to reach these applications. However, I hope that we will be able to address environmental problems. We know that climate change is a major challenge and synthetic biology has potentially a lot to offer, for example with carbon dioxide sequestration. There are also a lot of opportunities in food production. Our way of producing food contributes to and will be threatened by climate change. If we had better ways to grow our food or if we could invent new food, I think that could have a major impact. But again, people will have to understand and accept genetically modified organisms. Consumers still have the last word in the end.
You co-founded TATUM Bioscience, can you tell us about the goal of TATUM bioscience and what inspired that?
TATUM bioscience was initially started on a microbiome editing technology that could selectively and efficiently eliminate antibiotic resistant bacteria directly in the intestinal tract. However, the company rapidly pivoted for different reasons and is now creating a new type of immunotherapy to treat various types of cancer.
The main motivation for starting the company was to maximize the chances of societal impact of the technologies that we develop. We decided to be proactive and create our opportunities instead of simply hoping to potentially be noticed by pharmaceutical companies or VC funds. A crucial step was to submit patent applications whenever there was significant intellectual property to protect. We were also fortunate to be supported by the ACET National Bank incubator based in Sherbrooke and to raise funding with private investors. There are many programs to help create startups in Canada and this can be an interesting path for students interested in synthetic biology.
What advice would you give to students interested in pursuing a career in synthetic biology or related fields?
I would say that it is obviously important to master theory, laboratory techniques, and ideally bioinformatics (that’s a good tool that not enough people have) but my advice would be to cultivate creativity. Synthetic biology will reach its full potential only if we can imagine clever solutions to important problems. So, think about specific problems that you would like to solve and be creative. Then, go to your computer or to the lab and really try to change something. Another possibility that is important to consider for students is entrepreneurship. There is momentum being built in Canada for SynBio companies. Fundamental research is great, I really loved it, but another way to have an impact is to start companies and have products reach the market. I hope that many SynBio students will be interested in that possibility and that they will start companies. I have done it with a former PhD student and a colleague, others can do it too!
Dr. Sébastien Rodrigue’s work in modifying microbial genomes highlights the potential of reprogramming living systems. Looking ahead, he strives for the expansion of complexity, affordability, and safety in the synthetic biology field. Based on his experience with TATUM Bioscience, he hopes to inspire students to do the same, fostering innovation and driving progress in the field.
Quick Chat: Professor Mads Kaern
By Emma Lindsay - May 3RD 2023
Dr. Mads Kaern is a Professor at the University of Ottawa in the Department of Cellular and Molecular Medicine and cross-appointed in the Department of Physics. He has been part of the Synthetic Biology community since the early 2000s and started working in the field with Dr. James Collins on sources of "noisy" signals in gene expression and the engineering of programmable cell behavior by creating "plug-ins" for interfacing synthetic gene networks and natural signaling pathways. His NSERC-funded Synthetic Biology research uses an integrated genetic network engineering approach to study gene regulatory processes and develop artificial gene control systems. Dr. Mads Kaern initiated the uOttawa iGEM undergraduate training program and is the Co-Founder and CEO of Biogroupe Canada. He is also a member of the Cancer Therapeutics Program at the Ottawa Hospital Research Institute, and the Regional Genetics Program at the Children’s Hospital of Eastern Ontario.
What are some of the research projects you are currently working on?
I’m finishing up a big project that is looking at an iGEM inspired program that I launched during the pandemic to get students to do team-based learning similar to iGEM, and it was incredibly successful. This is research that I’ve spent most of my time on for the last three years, and I’m continuing to build the program and improve it in various ways. I’m just about to finish a paper, and I’m really excited about it. I can’t continue to research in this space because there’s no funding for it. So that's a little bit sad, but it's the right thing to do.
I also have two human health therapeutics projects in collaboration with scientists at the university. In one study, we want to improve the quality of pluripotent neural stem cells for cell-based therapeutics for neuroregeneration. What we want to do is try to use multiplex CRISPR to activate genes that are normally expressed in neural stem cells, but not expressed in induced pluripotent stem cells. That's a big issue because they look like neurons, but they’re not, so they’re not really good for transplantation. Even though these tools have been around for a long time, they’re not good enough yet for these particular applications. The efficiency is not high enough, and we know too little about it. What we want to do is target five or six transcription factors, which means that each of those guide RNAs has to be very efficient. We are hoping to be able to use yeast as a platform and do some large-scale screens to identify highly efficient guide RNAs. That involves a combination of cloning, bioinformatics, and maybe some artificial intelligence (AI) later on.
The second project, the long-term goal is to create microbial biosensor systems. These are complicated scenarios, but they are based on an idea where we have two chimeric antigen receptors that each have a binding site for different areas on a protein or virus, and only if those two come together, we will form a complex that then generates a biological signal. Individually, all those components are known, but they haven't been put together. We want to use that for a biosensor because we've used antigen nanobodies, and we can customize it to anything. We’re starting out with spike proteins because we already have so many different antigens available, so we can see if we can get it to work by optimizing that. Hopefully, we will be able to integrate it with intracellular signaling so we can create synthetic signals to junction pathways. One day, we will be able to have cells that have both the guide RNA machinery that can perform complex regulation of gene expressions and have a synthetic signal to junction pathways. That's where we get into my idea of creating smart biological devices which are cells that know where they are, sense their environment, and make decisions based on those signals.
What inspired you to get involved in synthetic biology?
I have a very hard time not understanding what I’m working on. So, what I find really frustrating about certain areas of biological research, is that the knowledge that is generated is very incremental and doesn't necessarily yield an understanding of how a system works. You can identify another phosphorylation site, on another protein, encoded by another gene, and you see some effect, but the ability to understand why you see that effect is extremely limited. The only thing you can really do is record what changes when you are disrupting the system. That’s knowledge, but it's not understanding. Understanding the causal relationship and how the system works is still beyond us, and I find that incredibly unsatisfactory. Synthesis is the highest level of understanding, it's the ability to use knowledge or data or information to create something. And that’s why I like synthetic biology. I thought if I can’t understand it by dissecting it, maybe I can understand it by building it. I first did chemistry in Toronto where I worked with infusion reaction systems where you are not just looking at a chemical reaction in a well-stirred environment, but you’re looking at an environment where you have flows, diffusions, turbulence, and all kinds of fascinating stuff that we know is important to life. But, we're still treating systems as these well-stirred chemical reactors, which is kind of nonsense, but it works remarkably well. Then this opportunity came about with the first programmable cells. So as a postdoc, I worked on creating the first prototype of programmable cells. We actually rewired the cellular machinery to respond in a certain way to an external signal. So that was very exciting. And at the time the fab was systems biology, and that is how I got to Ottawa.
What is BioGroupe Canada?
BioGroupe Canada is a non-profit organization that specifically offers a training program for undergraduates as an alternative to the iGEM competition. Taking some of the key elements of iGEM which is a vehicle for student learning and then addressing some of the deficiencies with the program, not only cost but also the disconnect between institutions and the biotech industry.
What inspired you to start BioGroupe Canada?
We lost funding for iGEM years ago in Ottawa. In 2018 or 2019 was the last time that I helped the team, and the students were really disappointed because they didn’t get to do much. There’s nothing tangible that they gained from it other than some lab experience. So I created another program during the pandemic which replicates many of those things and addresses some of those issues.
We also have to change the way we've been doing academics. One of the really impactful moments I had was when I was at the mall changing my Fido phone, and the person that was helping me said he had an Undergraduate degree in Biomedical Science from the University of Ottawa. He looked at me and said it was the worst decision of his life. So here’s a kid, with so few transferable skills in the real world. Probably with a lot of debt and a lot of regret. In these programs at the University of Ottawa, we are graduating around 1000 students, and it is really hard to see the transferable skills for 80% of them. It was embarrassing to me that we can’t do anything better for our students. That's when I realized we have to change how we do things in our undergraduate training. That's why I created this organization.
I’ve been working with some undergraduate students here in Ottawa because universities don't have resources for this either. It’s kind of like a student club. Hertek Gill has been in charge of developing a number of supplementary learning activities for undergraduates that can help provide and facilitate some of that skills training. The way that we're doing it here in Ottawa they have a student club that we call Bio Connect, and we are hoping to simulate what we had with iGEM where each university has its own cohort of students that would be able to participate in these activities but also propagate them at their own sites. But we're still working on developing these high-quality products, so we don't want to grow too fast because we want to have a strong core that can realistically be distributed.
You need to do something in outreach in terms of getting students involved early on and that requires a lot of work. That was what iGEM was for, but it's not working anymore. I would not advise any students today to launch an iGEM team. It’s just not worth it. The iGEM program is not structured in a way where you could get funding as a work-integrated learning program in Canada. It's not meeting the bar in terms of what is needed for student training. In many cases, synthetic biology stops. Like in fermentation, you create your bacteria, and then synthetic biology ends, and then other things have to take over in order to build the fermentation scale and marketing. You need to be able to offer training that allows students to reach either way. Let us say synthetic biologists have an entrepreneur mindset, which is inherent in synthetic biology, but also have these tools and skills that look for real-world opportunities and look realistically at translating this. Through iGEM you're not connected to a problem that is relevant to the industry in your area. Who is going to teach you the applications and what is needed for translation if you don't have that connection? You can't translate your skills into something that actually matters outside the academic program. And that's why I’m trying to change that.
You initiated the uOttawa iGEM undergraduate training program, what do you think is the key to having a successful iGEM team?
Depends on how you measure success. It’s very difficult to be competitive in iGEM unless you are a state sponsored team that puts money into it because they want to advance on the international stage. There’s simply too much work to do in order to be competitive. The idea of winning the competition is something that successful teams need to put out of their mind quite early. The most successful teams in my opinion are the ones that know why they're there. For individual team members, what is it they want to learn? What are the skills and competencies they want to develop? Also, the ability to work within a team, and find a way to collaborate within a very diverse team to be able to accomplish those learning goals while pursuing what appears to be a common direction. I would say that is how I believe students can get the most satisfaction, because they actually get something tangible out of it. Finding good academic advisors is very key, as maintaining social cohesion, and finding a way where everybody can be seen, heard, and contribute to doing work that is meaningful.
What do you see in the future of synthetic biology?
We have to tap into different resources. What does synthetic biology offer on its own that is unique, that you won't find in any other field? I know we can talk about synthetic biology as being integrated, but it doesn't have anything unique, in my opinion. In order to fund such programs, we have to demonstrate that there's a tangible benefit to those fields. We have to focus on the applied aspect, instead of thinking of synthetic biology as being something that stands on its own. Governments are worried about employment, and companies are worried about revenue. Those are what drives investment in science, research, and development. How can we generate jobs? How can we generate revenue? How can we increase the quality of life? We have to frame it in that way and build up the field based on regional strengths. For example, in Guelph, we would focus on the agricultural side, whereas Sick Kids is already focusing on anti-cancer therapies and oncolytic viruses. That's where I see that it's going. Training institutions will develop incorporating synthetic biology in ways that speak to their local strengths.
Do you think that Canadian research in synthetic biology is keeping up with other nations? What needs to change?
There is a reason why iGEM is in France, there is a reason why Tom Knight gave up his job at MIT to work at Ginkgo, and there is a reason why Drew Endy moved to Stanford. I think that Canada has done quite well. We have a really good return on investment compared to the U.S. It's not as exciting, it’s not as flashy, and it’s slower. We are lacking in the support where young entrepreneurs can go out, and have money to set up a lab and provide for themselves and their families for two to three years, without any expectations on return of investment. The U.S. is doing that, and it costs them billions of dollars, but that is earned home because one in twenty of those companies is gonna succeed and revolutionize. Some of it trickles down to synthetic biology. But that I think is the core issue, that we don't have the ability to create those entrepreneurial environments within academic institutions. Because if you do it this way, then the young entrepreneurs will come back to academia, and academia will be able to understand what skills and competencies are needed to be successful. That is an enormous hole that we have in Canada, in terms of supporting innovation in the bio-economy sector. We are doing well in Canada, and there is a lot of movement on specific initiatives, CAR-T cells are one, but all of those are transaction based, and once you see there's a big market, the government doesn’t care what you call it. You can call it genetic engineering, synthetic biology, or whatever. If it creates jobs, revenue improves the quality of life and helps Canadians, the government is interested. And it's up to us to demonstrate how synthetic biology is able to contribute to that. I think we need to not be so risk averse, provide more funding into entrepreneurial mindsets, and give young entrepreneurs a chance for a few years to build something they're passionate about and have the skills and abilities to do. But we're always looking for matching funding. We’re missing an entire layer of funding for people that innovate outside of the box. We are relying on existing companies wanting to invest in that. That's not innovation.
Dr. Kaern’s research in improving the quality of pluripotent neural stem cells and developing microbial biosensor systems are important advances in the field of synthetic biology. His organization, BioGroupe, will provide students with many opportunities to develop their skills training and gain some valuable experience as they continue their educational career, building a generation of professionals whose skills translate beyond their academic program as they enter the workforce. Dr. Kaern’s work can help the field of synthetic biology integrate into many different fields, accelerate innovation, and grow the economy.
Quick Chat: Professor Dr. Rebecca Shapiro
EMMA LINDSAY - 31 OCTOBER, 2022
Dr. Rebecca Shapiro is an assistant professor at the University of Guelph, in the Department of Molecular and Cellular Biology. She’s been at the University of Guelph since January of 2018, and runs a research group here where they study the genetics of fungal pathogens. Their research is centred around understanding the important genetics and biology of human associated fungal pathogens. They interface with the synthetic biology world by developing, optimising, and tinkering with new tools that manipulate the genetics of pathogens in order to better understand their biology, how they cause disease, and how they respond to antifungal drug treatments. They develop CRISPR based tools that are used to functionally manipulate the genomes of different fungi, and from there, address big questions in how genetics play a role in the biology of these organisms.
What are some of the current projects going on in your lab?
We always have lots of projects on the go. In reality, I don’t do any of the real research. I do lots of the thinking, mentoring, and guiding, but there's a fabulous group of graduate students, postdocs, technicians, and folks in undergrads in the lab that all have incredibly exciting projects, and have a lot of cool things on the go.
One of the things we've been really excited about, with regards to the development of CRISPR technologies and their use in fungal pathogens, is developing new CRISPR tools that allow us to very easily manipulate the genes in a diversity of different strains of a species. When we are talking about fungal pathogens, one of the main pathogens we work on in our lab is Candida albicans, which is a pathogenic yeast. It’s one of the most ubiquitous and common fungal pathogens in the world. It causes yeast infections, which are incredibly common. It also causes systemic bloodstream infections, which are very life threatening and occur in more immunocompromised people. This is a broad pathogen that causes all sorts of disease, and that's our main organism of study. Often when one develops these genetic manipulation tools, the focus is on working on a single strain background. But, with something like Candida, this is a clinical organism, it's found in most people, most of us have Candida in or on our bodies in a commensal state, but it can also cause these severe outbreaks and infections. There's also a real interest in being able to analyse many different strains, looking at different clinical isolates and how they're different from one another. To do this, we've been trying to develop CRISPR tools that are very easy to work with that can then be transported and used in a diversity of different types of clinical isolates or other kinds of isolates of these strains. A lot of the work that we’ve been doing has focused on developing CRISPR regulatory systems. The classic CRISPR, this gene editing idea, is what we often talk about. CRISPR cuts DNA, and we provide it with some sort of repair template to fix the break, and that allows us to incorporate a new piece of genetic materia so that it can allow us to insert or delete something from the genome or actually change the genetic code in some way. That's what CRISPR classically has been. A lot of what we've been trying to optimise recently is these regulatory systems which instead of actually manipulating the genome, allow us to use modified CRISPR to either upregulate or downregulate the expression of genes. Not the actual genetic code, but how much the gene is expressed, which allows us to control things more closely because we can turn down or turn up the expression of a gene. By turning down the expression of the gene, this has the benefit of allowing us to study essential genes, because those ones can’t be deleted, the cell would die, but we can turn down the expression which allows us to study them in a way that we couldn't before. Similarly, overexpression also allows us to study these different kinds of factors. We've been developing these CRISPR interference or CRISPR activation systems, respectively, that allow us to manipulate the expression of different genes to study their function, and has the benefit of being this very simple single plasmid based system that allows us to go into all sorts of different strains simultaneously, and again study gene function, not just in standard lab strains of Candida but also in all sorts of different clinical isolates.
There is a lot of circulation and news about CRISPR, do you think the public has a good conception of CRISPR?
That is a good question. It certainly is everywhere. I think everyone’s uncle or neighbour has sent them an article about this, or is asking those questions. It certainly entered the public understanding, it won the nobel prize last year, it's working its way into popular media in different ways. I think there's probably a reasonable surface level understanding of what it can do or that it’s genetic editing. There is certainly, at this stage, very prominent human therapeutics that are being developed with regards to CRISPR, so that is making its way into the people’s understanding. I think, as with anything genetic editing, it will always arouse some controversy or some mixed interpretations because of this idea of interfering with natural states or natural biology. There's always towing that line of trying to reach public understanding, while having an understanding of people's rational fears or concerns about things like this. I think it's important to nuance the application of these things, how we use them, when we use them, and how we consult with ethical guidelines.
What inspired you to get into synthetic biology and focus on CRISPR applications?
When I went to grad school, I did a PhD that focused on understanding the genetics of Candida so I’ve been working in Candida species for a long time. I would say that was more classical microbiology research. When I shifted to do a post doctoral fellowship after grad school, I went to a lab that was much more synthetic biology focused, and the focus there was much more on bacteria. There’s been a lot more rapid uptake of synthetic biology tools and techniques in bacteria for various reasons, they grow fast, they’re easy to work with. I was a person with fungal expertise from my PhD now in a synthetic biology lab, so it was a cool and exciting opportunity to start taking some of these tool kits and systems and try to apply them in fungi. I also started my post doc in 2013 which was right when CRISPR tools came into play. It was the very early days of the development of these tools, so it was a very exciting opportunity to try to co-opt these tools in fungi, where historically we just have far less access to genetic manipulation tools and techniques than we do in other species and other pathogens. It was a good moment in time and an exciting bridging of different expertise.
Do you have advice for new PI’s that are starting their career?
I think many people would agree it’s one of the best jobs there is. It is such an exciting, and constantly evolving and dynamic job. I mentor students, I teach, I write papers, I write grants, I do interviews. I kinda do whatever I want. I think the advice is, because it comes with a lot of freedom, I think what has been helpful to me is to try to focus on the parts of it I really like the most. Which is not always possible, everyone has to do things they don’t want to do, that’s also part of the job. But, because there’s so much freedom I am able to say yes to opportunities that I think are exciting and interesting. Focus on things that really exploit your expertise. By the time you've reached this stage, you've become an expert in something, so formulate what that niche is and who you are. I seek out, and say yes to opportunities that really allow me to grow in this area, my little corner of the research world. Also, working with people who you want to work with. The job is highly collaborative. I work with many researchers and PI’s but I also work with the students in my group, and there’s a lot of freedom and flexibility to who you want to work with, and that is an amazing perk of this job. I seek out people who I want to work with because we have things in common, and it's fun chatting with them. By seeking out the people that you want to engage with and spend your time with, this allows your work life to be much more fun and enjoyable.
The Shapiro Lab Research Team
In the long term, what are some obstacles you believe the synthetic biology field will have to face?
Some will come down to regulatory issues and hurdles. How much any of the tools can actually be used as therapeutics, or bred into new crops, or actually make it out into the world and the market. I think that becomes a huge hurdle, which then ties into public perception and the pressure of the people. If people really don’t want CRISPR edited plants in the grocery store, then that's what's going to trickle into policy. Communication with the general population and the policy makers becomes a big hurdle to the field. It’s very different in Europe to the US to Canada. There's very different public perceptions and regulations as a result. I think that says there is room for improved communication. You can see there's a diversity and spectrum of acceptance and perception.
Do you believe Canada needs any resources to help strengthen synthetic biology research?
I think there's general things that affect a lot of research fields that are not unique to synthetic biology. The constant discussion of how much funding we are injecting into research at the federal level is an ongoing source of concern for all researchers. Relating to that is how much funding exists for graduate students, who are the ones who actually execute the research. This has been an important topic of conversation recently because graduate student stipends that are paid for by federal granting agencies haven't changed in a very long time. The cost of living has increased significantly, so we're sort of hitting a crisis point for overall funding for research, be it for running the research program overall, or for funding and training graduate students specifically. We need money that funds labs, but also money that funds students, and that pays students a fair living wage, because that is changing, and we haven't kept up as a country. I think if we don’t keep up we will lose students, and students are the ones that are executing the research. Those are the folks that are really pushing things forward. If we start to lose the most excellent, prospective students, either they leave to another country or skip grad school altogether, that's going to be a significant issue. Money is an obvious answer, we always need money. But it's been great to see the synthetic biology community in Canada has coalesced. I know there's been big synthetic biology initiatives through Ontario Genomics or Genome Canada, and those funding agencies have started to build more in the synbio area, which is super great. I know that the Canadian iGEM teams have all started to connect more through cGEM and all these other programs. Also, building more conferences pertaining to synthetic biology, I know there's local ones that happen here in Ontario, and I’m sure there’s many others. There’s been all this really great momentum. That’s another important part, building up the research community which allows researchers to connect to one another, and share expertise, and resources.
Quick Chat: Christian Euler
Emma Lindsay - October 17, 2022
Christian Euler is the Co-Founder and Director of Strain Engineering of Phycus Biotechnologies. He completed his BSc in Biochemistry and BASc in Chemical Engineering at the University of Ottawa. He recently completed his PhD in Biochemical Engineering at the University of Toronto under the supervision of Radhakrishnan Mahadevan, where he worked in synthetic and systems biology
What is Phycus Biotechnologies?
We are a company that uses synthetic biology to power our fermentation processes. Right now we have a process where we make glycolic acid, primarily for cosmetics, although we are looking at other markets as well. I am in Sydney, Nova Scotia where we've built a demo scale facility up to 1000 liters, and I'm running that project. I’m also working with our employees to drive the development of new products using synthetic biology. The core of what we do is powered by synthetic biology, and we have a lot of fermentation expertise. We run the gamut designing and building the organism, and then bringing it up to a process scale and making a product with it.
Where did you get the idea to start Phycus Biotechnologies?
It came from my Co-Founder, Vikram Pandit. In his PhD work, he created a technology that could be useful and spin out into something marketable, and I was really interested in that. Even though my research wasn't really related, I had the skills and knowledge to be able to contribute, so we decided to work together. That was back in 2017 or so. At that point we were working in flasks, the 50 mL scale. We've since hired four people, one of them has moved on, we have some employees, and we've scaled up to 1000 liters. But, it really came out of his PhD work.
What markets are you looking to branch out to beyond cosmetics?
Glycolic acid is a huge commodity chemical that is used in a lot of different spaces. It can be polymerised into polyglycolic acid, which is used in a lot of packaging. It's a next gen polymer, a lot of food packaging people are interested in that because it is biodegradable and it has a lot of useful properties. It's also used to make solvents. Our core mandate is to reduce the carbon footprint of chemical production. Right now, glycolic acid is made from formaldehyde which is a byproduct of oil and gas, which is not great. A lot of solvents that are used for paints and industrial solvents come from glycolic acid. It's also used as a cleaner and disinfectant. It's one of these chemicals that has a really broad use base, which is part of the reason we went after it. Cosmetics are interesting because consumers are very interested in sourcing, whereas in these other spaces, people are less interested in that, it's more about the bottom line. I think in cosmetics, people have a bit more money and time to spend figuring out where the ingredients in their products come from because they're putting them on their face. There’s maybe a little more of a perception of risk there. The consumers in cosmetics are really driving the green transition in that world, and were working with that movement.
What does the typical day look like at Phycus Biotechnologies?
It’s tricky because there is not really a typical day. Right now, we are in a bit of a transition because we've run our 1000 liter process, and we've gotten all the information out of that process that we needed to get. That was a demonstration, it was about producing some product for a couple of smaller customers. It was more about generating information so we can then model the scale up to the next scale. Right now we are preparing for a 10x scale up to a 11000 liter reactor. Our typical days are a little bit boring because we are in the office in spreadsheets, putting together information. This includes technical information for engineering teams at the other site and also information for investors. When we are in full production mode we would have two week cycles. The first week we would be doing the fermentation, and we run it with the help of some technicians here. It runs 24 hours a day for the first three days or so, so that means being on shift. First shift is six to two, then two to ten, and then ten to the next morning, which would typically be me. That's on the plant floor doing technical work, working with this huge reactor that’s two stories tall, monitoring it, sampling, making sure that things don’t go wrong, and when they do go wrong, because that's inevitable, solving those problems. The second week would be taking all the data that we generated, processing it, turning it into meaning, and doing process improvement. Because every run you generate a ton of data, we dedicate that time to take all that information and see what went well, what can we do better next time, what tweaks will we make, doing inventory, and preparing for the next run. The person in charge of the synthetic biology work, he's in the lab manufacturing DNA, making strains, testing those strains. When we’re in production mode, we’re doing less or none of that. So it's a bit dynamic. There's a lot of things going on. There's three of us here and two in Toronto. We do have our areas of expertise here, but because there’s only three of us, we end up overlapping a lot and helping each other out, which is great. Our engineer has learned a lot of biology and our synthetic biologist has really gotten into the process side. I think for students of synthetic biology, startups are great environments. It's crazy, fast paced, and there’s lots of stuff going on, but it's a great opportunity to learn everything from end to end.
What inspired you to get into synthetic biology?
There’s a bit of a long history there. Coming out of high school I went to the University of Ottawa, and I’m not sure if they still have it, but at the time they had this research scholarship where you got to do research in the summer after highschool, going into first year, and then after first year, going into second year. I didn't know exactly what I wanted to do. I was in the biotech program which is a double degree in chemical engineering and biochemistry. I chose that because I couldn't decide between science and engineering, so I just decided to do both. I got this scholarship, and on the list of professors accepting people that had this scholarship, Mads Kaern was there. His description seemed interesting to me, as somebody just out of high school with very little understanding of the world. I got put on an iGEM project that summer, one of the first jamborees was that fall and I went to it, and I got really excited with the potential of it. In particular, I saw the potential in terms of emissions reduction in all different sectors, but mostly in chemicals. That was way back in 2008, and I've been involved ever since. I’ve had little breaks where I’ve tried different things, but this is what I’ve wanted to do since then, and here I am doing it.
How would you define synthetic biology?
To me, what it comes down to is doing forward engineering of gene circuits and building a microbe that you're interested in having some function. Synbio started with the toggle switch and the repressilator and these interesting academic exercises in the dynamics that we could produce by building gene circuits. Those early tools that were built are maybe not so useful when you're looking at the industrial scale and actually doing something with them. What we do might look a little bit different. The gene circuits we build are not complex. When you are scaling up to actually produce something, complexity is something you want to minimize, it adds risks to your process. I still think we're doing synthetic biology, even though the cloning work we do is much simpler than these really complex gene circuits that can do all kinds of interesting computations. I think there’s a real scale there of complexity, and you might even say that any GMO falls under the umbrella of synthetic biology. I'm starting to think that this idea of “synthetic” doesn't really make sense at all because humans think of themselves as separate from the rest of the world, but we're not, we’re a part of this world. So our interactions with it aren’t synthetic, they're natural. I understand that we need a name for a field so we can recognize it, but I think that traditional notion of building complex gene circuits is maybe limited, and when we think about synbio we can start to include anything where you're making these deliberate manipulations to get a living system to do what you want it to do.
Why do you think synthetic biology is an important field? What do you think it adds to the world of science?
To me, it really greases the wheels in terms of translation. I definitely consider myself a scientist through and through. I really love doing research and I think that doing research just to generate knowledge is extremely important. I think what's really cool about synthetic biology is it's given the tools and motivation to people to also take what has been done and turn it into something useful. For us, it's about making chemicals in a way that is better for the world. CRISPR work, which really falls under this world of synthetic biology, has the potential to really change the way we approach health. To me that's really neat and maybe that's what differentiates synbio as a separate field. It bridges the gap between knowledge for the sake of knowledge, which is important, and then also using that to create something that is useful for people. I think in the second half of this century, the vast majority of the products we use will come from biology and that's going to be really important and really powerful. I see that as the future, what the power of synthetic biology can bring for us.
Where do you see the field going in the next few years?
That one is a bit hard to say because I’m not necessarily doing academic research. So, it's a bit hard to know what is coming down the pipeline. What I'd like to see is a lot more work on what happens after you've designed your circuit. You’ve got your gene circuit, it can do a thing, then let's do some industrial work and figure out what that looks like in terms of a process. So I’d like to see more of that happening. What we're seeing now, especially in Canada, there's a small but really dedicated community bringing synbio projects to the world. There's quite a few startups like ours who are doing good work, and I want to see that continue. I want to see them working with academics and universities to be pushing the research to support that.
The work of Christian Euler and Phycus Biotechnologies in developing formaldehyde free, bio-based, biome friendly cosmetics and personal care products are contributing to reducing our carbon footprint and progressing the development of sustainable chemical products.
Quick Chat: Kevin Chen
Kevin Chen is the co-founder and CEO of Hyasynth Bio. He completed his Honors Bachelor of Science in Biochemistry at Queen's University and went on to start up Hyasynth Bio. Hyasynth Bio is a synthetic biology company that specializes in creating strains of yeast that produce cannabinoids. Cannabinoids are naturally occurring compounds found in the cannabis plant, two of the most popular being THC and CBD. Cannabinoids have applications in nutritional, pharmaceutical, and recreational-use products. Since Hyasynth specializes in engineered yeast, their platform is adaptable, efficient, and scalable. The yeast is grown in fermenters and fed sugar and water over the course of a few days, after which the end product is extracted and purified. The cannabinoids can be included in a variety of products including pills, oils, and topical formats. The goal of Hyasynth is to customize combinations of cannabinoids and find rare cannabinoids that can be beneficial for a variety of diseases.
EMMA LINDSAY - AUGUST 23rd, 2022
Kevin Chen is the co-founder and CEO of Hyasynth Bio. He completed his Honors Bachelor of Science in Biochemistry at Queen's University and went on to start up Hyasynth Bio. Hyasynth Bio is a synthetic biology company that specializes in creating strains of yeast that produce cannabinoids. Cannabinoids are naturally occurring compounds found in the cannabis plant, two of the most popular being THC and CBD. Cannabinoids have applications in nutritional, pharmaceutical, and recreational-use products. Since Hyasynth specializes in engineered yeast, their platform is adaptable, efficient, and scalable. The yeast is grown in fermenters and fed sugar and water over the course of a few days, after which the end product is extracted and purified. The cannabinoids can be included in a variety of products including pills, oils, and topical formats. The goal of Hyasynth is to customize combinations of cannabinoids and find rare cannabinoids that can be beneficial for a variety of diseases.
What is Hyasynth?
We are focused on genetic engineering of yeast for the production of natural compounds, but specifically cannabinoids. So instead of growing cannabis to get THC and CBD, we grow yeast. We are able to isolate those interesting ingredients, and do that in a much more efficient and sustainable way than growing cannabis. Right now the cannabis or cannabinoid industry is developing in a very bizarre way where on one hand, the science behind it, the endocannabinoid system, is super relevant to all kinds of human health, for example in cardiovascular and neurological aspects. There's so many things that cannabinoids tie into that is going to be a huge topic to research because of what it can do for human health. But at the same time, this system is tied to the cannabis plant and everything that it’s known for, all this narcotics stuff and there's a lot of noise, so the whole space gets looked at in a bit of a funny way. It's tied to this current supply chain and to this whole idea that you have to grow cannabis. For Hyasynth, we're saying we don't have to make cannabinoids using plants, we can do it using synthetic biology, and biosynthesis, and have a regulated, clean, and scalable supply for these things. We started out from scratch where there wasn't a whole lot of research done on these enzymes or the chemistry or anything about them. So it was a lot of basic research that we had to do in those early days to figure out how we actually biosynthesize cannabinoids inside a yeast cell. And on that journey, we came across some super interesting stuff, we developed some really interesting technology platforms. But in the end what we have are strains of yeast that produce CBD at levels that are competitive to the cannabis plant and that's what we’re on our way to commercializing now.
What does a day to day look like at Hyasynth?
You show up to work, you know who and what you’re working for. We all understand the purpose of the company and we’re all similarly minded where we all care about the future, the technology, each other, and how we progress ourselves in our career paths. There's a lot of mutual respect and a great team environment to work in where people are supportive of each other. There’s plenty of ways to build your expertise, skill set, try new experiments, and learn about the leading ways you can engineer yeast. My job day to day is to send emails and take phone calls. It's not very exciting. But I do love to meet new investors that are looking at synthetic biology that don't really understand it and want to learn more about it because it's part of an ongoing revolution, and that's exciting for me. I also love to hear about all the technology we develop at Hyasynth when we come up with new ideas or when we find some fun way to engineer yeast. That’s all pretty amazing to hear when we get breakthroughs like that. So I hear about those things and tell investors about how cool we are. That's what I do.
Is there a benefit to using yeast over other techniques?
In the end, every host organism has its own properties so yeast is one of the generally accepted ones where people know how to grow it and work with it. The genomic tools are pretty widely available and well understood so it's not like you're troubleshooting and falling more into discovery land. It grows quickly and easily, and it's not super sensitive to certain reactive conditions or contamination. So it makes a pretty good overall picture for a manufacturing system. Every organism will perform differently. There's research being done into new host organisms for other things as well, which is all very cool stuff. But, for at least the cannabinoid pathway, yeast is clearly the most efficient organism to host this pathway, and like I said, more so than cannabis itself.
How did you get involved with synbio?
I got into synbio through the iGEM competition back in 2011/2012 and at the time I was studying biochemistry at Queen's University. I had a super great experience. It opened my eyes a bit to the world of synbio and genetic engineering, which I was always passionate about ever since [I learned about] the idea of DNA and genomics as a blueprint for living things. The concept was always interesting to me. After doing IGEM, I got to know a couple people who were starting a synthetic biology company in Canada, which at the time was called Synbiota. It was through that experience with that start up company, and with these couple Canadian entrepreneurs that were bold enough to start a synthetic biology company here, that got me interested in the idea of starting a company as opposed to joining the industry or joining academia. I thought that was super awesome because I was coming from this IGEM experience of we’re a team, we’re coming up with our own ideas, we're solving these problems, we're thinking about how this actually exists in reality, and I loved all of those things. It wasn't like I had one thing where I loved technology or science, or I loved the effect on society, or the economics of it. In the end, all of it coming together was what I loved the most, and working as a team was also a big part of what I liked about that. After being connected to the start up I also started my masters degree at McGill University and during that degree was where I felt like I was taking a step back cause the environment was such a contrast to what I was already getting excited about. Once the opportunity came around to start Hyasynth, I knew this was what I really wanted to do, and starting a synthetic biology company is the best thing for me. At the time we were among the first companies in Canada to really focus on synthetic biology. That was in the year 2014, where we kicked things off and that's when we got founded. That was also when I dropped out of my masters degree at McGill and did this full time.
Why do you think synthetic biology is such an important field?
Some people define synthetic biology as some kind of sub-sector of biotechnology as a whole but really, think of synthetic biology as anything genetic engineering related or something that is geared by synthetic DNA. Even every mRNA vaccine we've seen to date or DNA-based vaccines that are helping us with COVID stuff, that’s all synthetic biology. How can you look at that and argue that there’s no impact of synthetic biology? Because it clearly defines the world. The investment towards it is super clear from the human health standpoint. Where it also gets interesting is when you look at the agricultural impact as well. Which is a bit more where Hyasynth applies. We're going to replace an agricultural process with a fermentation process and have a massive benefit to the carbon impact and human health by doing so. There's quite a few companies that do lean in the direction of what other parts of manufacturing or society can be improved by synthetic biology. But anywhere where there's a microorganism or a living thing that can be worked with at the DNA level, there's an opportunity for those things to be improved or better understood through the study of synthetic biology. And even beyond that, you can consider very cool things like the use of DNA and data storage as another branch of synbio that is on its way. There's other fun things with aptamers or RNA ribozymes that fall into the category of synthetic biology because they’re still based on synthetic nucleotides. Those are fields where they’ll change things about diagnostics or changing the analytical chemistry that are on their way too. Synbio is already the root of a lot of what we do. It might boil down to a way of thinking around it. This is a point I do want to stress when it comes to a lot of synbio. When you think about the tools that we have to do research, to do science, to solve a problem, that's where the tools are starting to change a bit. Where you might’ve originally had the idea of chemically synthesizing cannabinoids, that would be the easy way to do it, that's the way we can do it scalably, there's no such thing as a yeast that can produce cannabinoids, that's impossible. But these days, it's actually quite possible and quite easy to realize. It becomes clear how to engineer yeast to do these things. Or even the mRNA vaccine where it was super relevant for COVID stuff, but the original story with a lot of the mRNA vaccines was more around oncology. So the platform was transferable. That’s the interesting thing that you can change about the way research is thought about and how these tools are looked at. Once you can synthesize DNA and use that for a problem, that can be reapplied in a lot of different ways and you start to see a lot of platform based approaches on things. Start to think of DNA or RNA as a tool kit or platform that can be engineered or tailored to whatever need you have. I think that's the big difference between biotechnology of yesterday and synthetic biology of today.
What do you think is the biggest obstacle for synthetic biology research?
In some ways I feel that the barriers come down all the time. DNA used to be too expensive, sequencing used to be too expensive, the equipment used to be expensive. But everything keeps getting better and cheaper and it's becoming more and more competitive to produce the tools for doing this kind of work. You could talk about society and regulations as some type of barrier. But that's not really a barrier because on some level, you and I define the regulations through democracy. You can vote for people who will put the regulations in place that we think make sense, but it's also our responsibility to drive those things at the same time. In some sense, I could say the major barrier of a lot of synthetic biology stuff is not doing more of it or not trying hard enough to look at the barriers that are preventing you from succeeding. Even the idea of critical thinking around what your barriers are. If your barrier is that NSERC won’t give you enough money for this stuff then get a bunch of professors together and write some big letters to NSERC until you convince them otherwise. If your barrier is really about consumer interest or public interest or public perception on GMOs, then put some readers to that, do the work. I think people tend to throw their hands up in the air a bit and say that they’ve hit a barrier, it’s not a barrier, it’s something that you gotta fix. And you’re the ones that got to do it. There’s a lot of work that has to go into it before it becomes a clear, established process.
Do you have any advice for a student who is looking to get involved with synthetic biology?
Come work for Hyasynth is one. Two would be go join SynBio Canada. Three is to start your own synthetic biology club at school, or join an iGEM team. Just find ways to get involved and dig into it. Start to do it. You could take the traditional approach and find internships or find professors and start working with them but I think in a lot of cases, especially in this field, a lot of these things are going to be things you start from scratch. Even build a lab in your garage. That's the way a lot of people have gotten into synthetic biology. That's what I would recommend for students.
Quick Chat: Professor Dr. Brian Ingalls
Dr. Brian Ingalls is a professor at the University of Waterloo in the Department of Applied Mathematics. He is also cross appointed to the Departments of Biology and Chemical Engineering. Dr. Ingalls’ research is focused on synthetic and systems biology. His lab is the Ingalls Quantitative Cell Biology Lab at the University of Waterloo, where his group utilizes mathematical and computational tools to build and analyze kinetic models of biomolecular systems. Their focus is on intracellular networks and heterogeneous microbial communities. Currently, their projects are centered on model-based design of synthetic bacterial gene regulatory systems.
EMMA LINDSAY - AUGUST 10, 2022
Dr. Brian Ingalls is a professor at the University of Waterloo in the Department of Applied Mathematics. He is also cross appointed to the Departments of Biology and Chemical Engineering. Dr. Ingalls’ research is focused on synthetic and systems biology. His lab is the Ingalls Quantitative Cell Biology Lab at the University of Waterloo, where his group utilizes mathematical and computational tools to build and analyze kinetic models of biomolecular systems. Their focus is on intracellular networks and heterogeneous microbial communities. Currently, their projects are centered on model-based design of synthetic bacterial gene regulatory systems.
How did you get into synbio?
When I was finishing my PhD, I was working with feedback control systems and my advisor pointed me to some recent stuff that was being done in reverse engineering a biochemical regulation. I went to a talk by Michael Elowitz, who presented the repressilator. I had no biology up to that point, and I was just blown away that it was possible to do that kind of engineering project in that space. And then I got lucky, and I ended up in a postdoc group doing engineering and biology.
What are some of the projects currently going on in your lab?
Bacteria mediated cancer therapy. This is something that most people have never heard of. In the mid 1800’s, it was observed that sometimes cancer patients got bacterial infections and if they survived, sometimes it helped with their cancer. People played around with it, but they did not really understand what was happening. And then, chemotherapy and radiotherapy were developed, and it fell off the radar because people had better ways to address cancer. It's come back a little bit, people are renewing their interest in it because of the means we have now to manipulate the bacteria doing this. The basic idea is that anaerobic bacteria solve in a particular way the targeting problem. In cancer therapy, one of the biggest problems is targeting cancer cells, and not targeting healthy cells. The feature that bacteria mediated cancer therapy was taking advantage of is that a lot of cancers produce these solid tumors, and these solid tumors have trouble being properly oxygenated, so you end up with this mass of cells that have poor access to oxygen. This produces an anaerobic environment inside the person's body. So, if you have cells or spores of anaerobic bacteria, you introduce them into a person. Those cells, if they find their way into the anaerobic core of that tumor, can proliferate and propagate. And if they don’t, they just get cleared since they are inert. So that is an interesting way of solving this targeting problem. People have been looking at this over the last couple of decades in terms of engineering those cells so that they can do different things. Naturally, as they grow, they can chew out some of the cancer cells in the area and elicit an immune response because there's this infection going on so that can help with the cancer remission. But also, you can engineer the production of drugs or prodrugs. We’re looking at the Clostridium species and we're doing some engineering with that to do two things: one is to introduce a quorum sensing mechanism so that the activity can be turned on when they reach a significant population density in this tumor environment and have targeted activity in particular areas; the second thing is we are also looking at increasing their air tolerance so that they can proliferate a little more than they normally could in that environment to have the effect that we need.
Optimal experimental design. It was established one hundred years ago in the early 20th century for linear descriptions on how experiments depend on the set up of the experiment. The basic idea is that if you have a particular objective for your experiment and you have a limited set of resources that you can expand your project on, then which resources should you choose to address the goal of understanding the system in a particular way? In the linear space this is a nice theory and applies when you make these assumptions about a system's behaviour linearity, which is not typically the kind of thing you see in biomolecular networks. If you take the same theory and try to apply it to more complicated linear scenarios, for example dynamic systems, then you have the same kind of questions. Which experiments should I do? One basic question first is if you’re taking a time series, where do you choose your time points? That's the kind of questions that one can address. So recently we’ve developed tools and some software packages along those lines that essentially allows folks to do that kind of analysis.
An example of the optimal experimental data. Graph by Nathan Braniff, PhD Candidate
Behaviour of bacterial communities. We're looking at baby versions of bacterial ecology. Bacterial ecology is very complicated and it’s very difficult to characterize what is going on in those systems. What we do in the lab is we set up very simple communities and start with characterizing their behaviours and working towards things that are more complicated. We are looking at things like horizontal gene transfer, phage infections, and more generically inhibition in terms of a diffusible toxin release from cells or a contact dependent effect. The tool we have for characterizing these systems is time lapse fluorescence microscopy. We have a set up that allows us to image the entire population in a single focal plane and we add fluorescent markers to these cells to indicate their state. We can run these experiments for twenty-four hours or more and we can watch the cells propagate and interact. What we have alongside that data is the characterization of the data in terms of these dynamic models. One opportunity is to use this modeling structure to understand how these systems behave, for instance to infer things like conjugation rate, growth rate, and effective conjugational growth. The goal here is to eventually use these models for model-based design of manipulation of these systems. These systems are in lots of different environments and being able to manipulate them sounds promising.
Image by Aaron Yip, PhD student.
You use mathematical and computational tools for your projects. Are these techniques common in synthetic biology?
The main mathematical tool the group uses is kinetic modeling to characterize system behavior and explore possibilities. That can be either the reverse engineering of systems to better understand what is there, or from a forward engineering perspective, model-based design. We can build models with some degree of accuracy in terms of prediction and that’ll allow us to explore design space much more cheaply than you could running batches and batches of experiments. I would say it's fairly common. There are lots of people that go into life science and have an aversion to computation. That's changing. There was a time when a lot of people in biology spent their whole careers and did very little computational work. The human genome project was a breakthrough for bioinformatics being identified as a key part of molecular biology. This kind of work is a bit more esoteric. Standard bioinformation is about things like genome analysis, sequence alignment, working with static data, and there's a lot of that data available. This kind of work requires more data to put these kinds of descriptions together. That kind of data is hard to collect, it is expensive to run these experiments so it's often not the first thing people do. I like to think it is becoming increasingly more common, but I wouldn't say it's very common. But there are lots of projects where it's an important piece and it's becoming a more valuable tool as people recognize that the data is available. The basic idea is that the systems are very complicated so in every other branch of science when you hit a really complicated system you need to turn to these tools to understand.
Are there any resources that Canada needs to help strengthen the field of synthetic biology? Where do you think Canada can improve?
Canada's economy is based on resource extraction which comparatively doesn't require a lot of R&D. That's been the basis for the economy since the country was founded. That is in part what has led to a sort of risk aversion in terms of investment, both private and public, so Canada is often lagging when it comes to new technologies and risky technologies. We do have certain strengths for sure. The educational system is great at producing people who can do this sort of work, and who are interested in this sort of thing. I think there's a lot of promise, and there certainly could be more delivery on that promise if we had more investment.
Are there any applications or techniques in the synthetic biology field that you’re excited for?
There's a lot of short term promise in biomanufacturing. Improving biomanufacturing is an iterative improvement, and so that does seem to be an area that the community is continuing to embrace as where there will be lots of impacts of synbio. One of the basic questions is about the release of organisms. So, if you're going to make an organism and you're going to use it, you have to set it free into the environment. People are understandably nervous about that. There are lots of discussions, and I don't think there's going to be any problem there. If you can have your advantage in the lab or the factory, and you never have to have that discussion, then it makes life a lot easier.
Do you have any advice for someone that wants to get involved in synthetic biology?
I could say two things. One is networking. There are groups and communities such as iGEM, and there’s always an opportunity to reach out. There are lots of opportunities to get involved even at the high school level. That’s something people should keep in mind. And the community is very welcoming and happy to have people interested at all stages. The other thing I would suggest in planning an education that could lead in this direction is being open and trying to embrace ideas across disciplines. A lot of educational programs are very siloed and disciplinary. Especially as an undergrad, that's how the program is set up and that's what you do. You take the courses you need to take. Seek out opportunities to expand that toolbox. Given that synbio is a relatively young field and a very interdisciplinary field, the best positioning one can have as a junior researcher, or someone interested in entrepreneurship is to get exposure to as many as those things as possible. So do a little bit of computing or entrepreneurship or life science or bioinformatics. Often one must be proactive about reaching out cause standard programs are typically very siloed and disciplinary.
Dr. Ingalls’ research in developing mathematical models is important for the field of synthetic biology. These models can help predict behaviours of intracellular networks and cellular communities, help build an understanding of complicated systems, and help further the progress of synthetic biology research
SynBio Canada Publishes Editorial “Facing the Paradox of Openness to Build Resiliency in Canada’s Bioeconomy"
Fabian Rohden (Science Policy Lead) and Dr. Benjamin Scott (President) have published a editorial as part of the Canadian Science Policy Centre’s 2022 series Building Resilience During International Crisis.
The editorial examines the paradox of openness, whereby the openness of nations is both the cause and solution to several ongoing international crises. This paradox also extends to Canada’s bioeconomy, where the openness of genomic data and infrastructure must be carefully considered.
Read our editorial to learn more: Facing the Paradox of Openness to Build Resiliency in Canada’s Bioeconomy.
The BioExperience Program
The BioExperience program was an interactive and collaborative learning experience in which teams of 6-8 undergraduate students from a wide variety of programs and faculties worked together on various self-guided projects related to synthetic biology. The 2020 BioExperience Program consisted of 7 different teams which investigated various topics ranging from removing microplastics from wastewater to creating a 3D bioprinter.
Hertek Gill - April 22, 2021
Design of the clarifier insert for wastewater treatment tanks created by the BioEnvo team and presented at the cGEM 2020 conference.
COVID-19 has affected the world in many ways but one effect of the lockdown that has hit university students hard was the sudden loss of many summer employment and co-op opportunities. Many students rely on these opportunities to fund their education and to gain vital job experience in their field of study. Due to the lockdown, many traditional student employers were, unfortunately, unable to host students over the summer. It was amidst these unprecedented times that Dr. Mads Kaern of the Faculty of Cellular and Molecular Medicine at the University of Ottawa started the BioExperience program with support from the University of Ottawa and BioTalent Canada. This new program would provide over 50 students the ability to work over the summer as well as the opportunity to gain the experiences and skills needed to initiate a career in biotechnology with an emphasis on the engineering of biological systems at the cellular and molecular level.
The BioExperience program was an interactive and collaborative learning experience in which teams of 6-8 undergraduate students from a wide variety of programs and faculties worked together on various self-guided projects related to synthetic biology. The 2020 BioExperience Program consisted of 7 different teams which investigated various topics ranging from removing microplastics from wastewater to creating a 3D bioprinter.
Students in the program were involved in every step in the research project from formulating the research question, creating a plan, interviewing and hiring other students, organizing and distributing the workload, and summarizing the results into publication-quality reports. This allowed for a large potential for growth as students learned to independently do the various tasks associated with running a research project.
The group setting with fellow undergraduate students created an environment where discovery and trial and error were promoted as everyone was learning how to organize and manage a research project together. This created a very collaborative and encouraging environment where everyone was able to speak during lab meetings and have their ideas considered. The inter-faculty nature of the groups also provided many students with their first exposure to working in interdisciplinary teams as most other group projects at the undergraduate level are done with peers in the same program. This allowed all the students to experience working with people with a completely different knowledge base and using these different backgrounds to the advantage of the group as a whole. This skill set will be very beneficial to all the students in future endeavors where they will have to coordinate with different departments at their place of work.
Another aspect of the program that was very influential in making the experience rewarding were the various training sessions held throughout the summer on topics such as doing research using the library’s virtual resources and how to cite work. These workshops helped teach important skills in an environment where they would be immediately applied, allowing students the opportunity to use and refine the skills without forgetting them.
COVID-19 testing kit designed by the COVID-ENG Team.
Throughout the summer each student conducted both self and peer-assessments of their fellow teammates. These assessments allowed students to understand their strengths and weaknesses so that they could understand what they could work on improving over the summer. Self-reflections were important as they allowed the students to think about what they have accomplished so far and what they personally see as their next steps. Students were then able to compare their reflection with the anonymous assessments their peers made of them to understand if they missed something. These moments of reflection ensured that everyone stayed on course over the summer and could utilize the remaining time to improve themselves as much as possible.
At the end of the 4-month program, every team submitted their work in a series of reports, schematics, and diagrams. The final day of the BioExperience Program was the Closing Ceremony. This one-day event featured presentations from each team, speaker panels as well as prizes for the various teams. This event was a culmination of everyone’s hard work and allowed everyone to showcase their work to their peers, faculty, and family.
After the summer, one of the BioExperience teams was chosen to present their work at the first annual Canadian Genetically Engineered Machines. Here the BioEnvo team was able to capture a gold medal and the award for the “Best Collaboration” for their close discussion with experts in the field, other research groups, and universities. The BioEnvo team consisted of 3 subteams which each worked on a different aspect of the project. The three sub-teams included the Microplastic Filtration sub-team, which designed a clarifier insert for wastewater treatment tanks; the Microplastic Remediation sub-team, which determined the necessary steps to process the collected microplastics, and the Microplastics Biodegradation sub-team, which focused on enzymatic processes to degrade microplastics. The final product of this project was a theoretical system that can remove microplastics from wastewater, using magnetite powder to create magnetic clumps of microplastics, which could then be easily collected. These collected microplastics would then be taken to a separate facility where they could be degraded by PETase enzymes inside a specifically designed Bioreactor facility.
The team not only focused on the science behind the project but also developed a viable business plan and pitch presentation to show potential investors. The pitch focused on the business aspect of the BioEnvo project and the benefits, both environmental and financial, that would come from the implementation of this project to remediate and recycle microplastics from the Ottawa River.
In the end, the BioExperience program was an experience like nothing else a student at the undergraduate level experiences in university. This program’s blend of problem-based learning with collaboration amongst an interdisciplinary team allowed every single student to develop many skills that will be vital to them in the job market. This program provided an experience that will have a profound impact on how students perceive the job market and their place within it. As a student who has experienced the first iteration of the BioExperience program, I would strongly encourage students to take the opportunity to be a part of this program as it will help them improve a multitude of skills and will leave them better prepared for anything that lies ahead. If your university does not offer such a program, strongly consider discussing this with the administration as a BioExperience-like program would be very beneficial to all students in terms of the experiences it provides to its participants.
An Interest in SynBio - The Perspective of a Canadian High School Student
I learned about synthetic biology 7 months ago, in September 2020. Over the summer, I first learned to code in Python, then in JavaScript, and now in Java. When I first heard about the development and application of computer science techniques to biology, I was hooked.
Ammielle Wambo Becker - April 22, 2021
Despair and anxiety are not uncommon feelings among young people these days. As high school students, we deal with many sources of stress, from parental pressure and high expectations to mounting workloads. It's not easy to juggle all this, not to mention the growing concerns about the future, whether it's because of the climate crisis or the coronavirus. But I am optimistic about one thing: synthetic biology.
https://pixabay.com/users/qimono-1962238/
I learned about synthetic biology in September 2020. Over the summer, I first learned to code in Python, then in JavaScript, and now in Java. I enjoy the creativity of debugging code and solving problems and the collaboration of participating in hackathons and competing as a team. When I first heard about the development and application of computer science techniques to biology, I was hooked. The exciting idea of programming a cell with the code of life, DNA, as I would with any other programming language, led me to biological computing.
Biological computing is concerned with the creation of biocomputers, i.e. biomolecules capable of performing calculations. I dove into DNA digital data storage and synthetic biological circuits as a way of demonstrating the computer-like properties of biological systems. Although I didn't know it at the time, I was just covering a small area of the field of synthetic biology.
I don't really know what about synbio is special to me. Maybe the field is just so emerging and I feel I can make a real impact. Maybe it's such a multidisciplinary and broad field that I don't have to choose a specialty yet. Maybe it's really a matter of optimism: synthetic biology shows great promise. Or it is a blend of all these reasons and more. I can see myself tinkering and engineering with biological elements for a long time.
I think the COVID-19 lockdowns have been both a blessing and a curse for my learning journey. On the one hand, more synthetic biology webinars and conferences are being held virtually than ever before, and thus I don't have to worry about cost or travel distance. I can gain invaluable insights and meet other people through Zoom! On the other hand, although I would love to gain the technical experience of working in a wet lab, I have never set foot in one. I’ve learned everything I know from articles, papers, and videos, as well as from insightful conversations with researchers and professionals.
It is often discouraging that so many opportunities and courses are reserved for post-secondary students, but I understand why. Because we lack the experience and knowledge to participate in technical courses and challenging events, high school students are rarely the target audience. Yet I always wonder why there are hardly any opportunities for us to get involved in biotechnology, to gain this necessary experience and knowledge. Few people around me (and even fewer people my age) have ever heard of CRISPR or synthetic biology. Despite the online learning content for beginners, entering this space can still seem intimidating and daunting to many. And even after taking the huge first step of outreach and awareness, I think that presenting enrichment materials and opportunities for a strong and diverse future biotech workforce is often missing. Even if young people know what synthetic biology is, how can they foster their interests? How can they pursue these fields beyond the classroom?
A good start would be to provide young people with mentorship and advice from researchers. I also think that research projects and placements play a key role in exposing students to potential career paths and supporting their interests. And why not launch courses with live lessons and virtual communities for young biotech enthusiasts across Canada to connect with others and share interesting articles and papers? Why not hold biotech challenges, case studies, or sprint-like events for students of all levels? While I cannot speak to the logistical or financial requirements of providing such opportunities, they could only empower young people to engage responsibly with synbio, to express diverse perspectives, to take an interdisciplinary approach, and to pursue careers in the Canadian bioeconomy.
SynBio Canada Publishes Policy Memo in the Journal of Science Policy and Governance
Canadian post-COVID-19 economic recovery efforts have been framed around values aligned with Canada's commitments to the United Nations Sustainable Development Goals (SDGs), primarily concerning environmental sustainability. The field of synthetic biology (synbio) offers many innovative ways to achieve these goals while growing the economy.
A policy memo drafted by members of the SynBio Canada Executive Team was recently published in the Journal of Science Policy and Governance. The memo entitled “Invest in Canadian Synthetic Biology to Meet Commitments to Sustainable Development and Support Economic Recovery” adds to the chorus of calls for dedicated funding of synthetic biology in Canada.
The memo was initially written before the COVID-19 pandemic, then updated many times to stress how important synthetic biology is for our future.
Abstract: Canadian post-COVID-19 economic recovery efforts have been framed around values aligned with Canada's commitments to the United Nations Sustainable Development Goals (SDGs), primarily concerning environmental sustainability. The field of synthetic biology (synbio) offers many innovative ways to achieve these goals while growing the economy. Here, we discuss the opportunity for Canada to become a leader in clean technology applications of synbio. Investments in synthetic biology, which has traditionally been underfunded compared to other countries, will have beneficial impacts on the environment while driving Canada's post-pandemic economic recovery.
cGEM Part II: The Workshops
While the cGEM 2020 conference provided a platform for Canadian iGEM teams to showcase their work, this event also fostered conversations on many aspects of synthetic biology with students, industry leaders, and academic professionals.
Fatima Sheikh - January 26, 2021
While the cGEM 2020 conference provided a platform for Canadian iGEM teams to showcase their work, this event also fostered conversations on many aspects of synthetic biology with students, industry leaders, and academic professionals. The conference was kicked-off by Dr. Bettina Hamelin from Ontario Genomics discussing the biological innovations that are being pushed forward as a result of the COVID-19 crisis. This inspiring keynote set the tone for what was 2 days filled with many different talks and important discussions on the vast applications of synthetic biology in Canada.
On day one there were a series of interactive workshops that allowed students to explore different avenues/aspects/components, important in the field of synthetic biology. The After iGEM team, directly from iGEM HQ, held an important workshop on scientific communication! To put it simply, research does not matter without effective communication. Scientific communication is required at every level of research whether it be in the beginning when acquiring funding, throughout while recording results, and especially at the end when relaying this information to stakeholders and the public. A strong emphasis in this workshop was put on knowing your audience. Is this information being presented to other professionals in the field, or is it being relayed to the public? Breaking down the language used is critical to ensure understanding of the material and knowing your audience can ensure that there are no misunderstandings. As members of the growing synthetic biology community, part of our responsibility is to ensure proper engagement of the public and this was highlighted by the After iGEM team and discussed throughout the remainder of the conference.
On day 2 we began with a series of fireside chats, one which included Dr. Benjamin Scott (SynBio Canada) along with Avalyne Diotte and Pierre Oliver (Policy Horizons) discussing what they’ve learned from the ongoing biodigital convergence webinar series. Together, they answered a number of questions and ultimately highlighted the potential of synthetic biology techniques and approaches that can be used to build on existing knowledge and infrastructure within Canada. But, how do we make this transition to the use of synthetic biology and its different applications in a way that engages all the important stakeholders? They suggested that part of it will come down to good science communication and with the recent pandemic, health and innovation are at the forefront of public discussion, providing scientists of all disciplines an important learning opportunity.
Later on during the day, a series of panels were held, one of which covered the topic of synthetic biology education. This conversation was moderated by Bi-ru Amy Yeung (cGEM co-director and co-founder), and included expert voices from Patrick Diep (CSBERG co-director and founder), Dr. Vincent Martin (Concordia), Magda Pop (MindFuel), and Orly Weinberg (Concordia). They highlighted the synbio education landscape in different regions of Canada and the progress that has been made over the past few years both at the high school and the post-secondary level. Moving forward, they encouraged the integration of project-based learning and re-framing human practices, referring to the social and ethical impacts of research, to improve integration with other domains of synthetic biology research. With students being an important part of the synthetic biology community future, a strong emphasis on educational programs that highlights both the technical skills along with other important aspects, such as science communication, will equip synthetic biologists with the tools to contribute to the bioeconomy.
This recap of the cGEM conference wouldn’t be complete without a discussion on the Equity, Diversity, and Inclusion in Synthetic Biology panel. It featured Dr. Trevor Charles (Waterloo), Kelcie Miller-Anderson (MycoRemedy), Dr. Nika Shakiba (UBC), and Peivand Sadat Mousavi (University of Toronto) and was moderated by Dr. Rebecca Shapiro (Guelph). Together, they fostered a discussion on roadblocks experienced by minorities and how each of them overcame their own obstacles. These individuals are inspirational, to say the least, with their stories providing proof that anything is possible with a strong support system. Suggested advice to young students and prospective synthetic biologists included making connections early and finding supportive mentors. Mentors can provide insights into how to elevate your career but are also important for navigating potential barriers. While there are strong efforts toward making the field of synthetic biology more diverse and inclusive, there is still a lot of work that needs to be done and will require each of us to do our part in creating a more equitable and diverse community.
This conference was wrapped up with a keynote by Dr. Ryan Pillipe from Genome Canada, where he shared insights into how students can contribute to the Canadian bioeconomy, followed by reflections from Amy Yeung (UofT), Jehoshua Sharma (Guelph), and Luana Langolis (Western) on the conference and future of synthetic biology. We think it’s safe to say this year's conference was a success, and while we only highlighted a few sessions from the conference, every session had fostered important discussions between students, researchers and industry professionals. As we continue to grow this community and leverage synthetic biology to improve society, effective knowledge translation and engagement of the public as well as active efforts to create a more equitable and diverse community, are going to be important drivers of this growth.
Thank you to everyone who attended this conference, if you missed any of the amazing sessions you can find the recordings on the cGEM Youtube Channel. Be sure to keep an eye out for next years events and initiatives by following @cGEM_2020
List of cGEM 2020 Workshops
Pitch Fundamentals by Forest City SynBio
Scientific Communication by After iGEM
Scientific communication is extremely important with 6 main keys
Stakeholders: people depending on the research
Scientific method: this includes disseminating results
Public perception
Funding
Communication skills
Sustainability
Lean Business Model Canvas by Danielle Rose from SynBio Canada
Translational Synbio by Synlogic
Inscripta Keynote by Chad Whitman
Biodesigning our Future by Ginkgo Bioworks
Digital Bioconvergence by Synbio Canada and Policy Horizons
Community Science by Open Science Network
Equity, Diversity, and Inclusion in SynBio Panel
Environmental Sustainability in SynBio Panel
Canadian Start-Ups in SynBio Panel
Canadian Education in SynBio Panel
Genome Canada Keynote by Ryan Philippe
cGEM Keynote by Jehoshua Sharma, Amy Yeung, and Luana Langlois
cGEM Part I: The Teams
The first-ever Canadian iGEM (cGEM) conference was held on October 3rd and 4th. With over 240 participants registered, 10 iGEM teams presenting, 4 workshops, multiple panels, and keynote speakers, this event fostered important synthetic biology discussions.
Nicole Leblanc - October 29, 2020
While many events and conferences were cancelled this year due to the pandemic, the first-ever Canadian iGEM (cGEM) conference was held on October 3rd and 4th. With over 240 participants registered, 10 iGEM teams presenting, 4 workshops, multiple panels, and keynote speakers, this event fostered important synthetic biology discussions. This inaugural trainee-led conference was organized by iGEM members across the country, led by iGEM alumni and synthetic biology enthusiasts, Jehoshua Sharma, Bi-ru Amy Yeung, and Luana Langlois who saw a need for a trainee-focused synthetic biology conference.
The year of 2020 will certainly be remembered for generations to come as the time when ‘unprecedented circumstances’ interfered with plans for the future on a global scale. This was no different for Canadian iGEM teams as many were forced to make the difficult decision to not participate in the (rather expensive) international competition this year.
Having recognized the educational value of the experiential learning opportunity facilitated by the iGEM competition, the cGEM steering committee sought to develop an all-Canadian version of the competition at no cost, which aims to contribute to the creation of training opportunities for young trainees in the country and better reflects the organization’s values: academic ingenuity, entrepreneurship, fostering public trust, and promoting interdisciplinary action. To this end, the organizers developed their own judging criteria, which placed a stronger emphasis on entrepreneurship. Also, many teams were unable to access labs as they normally would and so the cGEM competition criteria was focused on project design, collaboration, and peer review.
The cGEM criteria was used to judge the teams not participating in the iGEM competition, while the teams attending the online iGEM jamboree were judged by the iGEM Medal criteria so as to minimize the duplication of efforts for the latter teams. From the teams that are not participating in the iGEM competition this year, three teams were awarded a gold medal, the University of Guelph, the University of Ottawa, and the University of British Columbia, one team was awarded a silver medal, McMaster University, and one team awarded a bronze medal, the University of Toronto.
Of the teams that are participating in the iGEM competition this year, there were 2 teams awarded a gold medal, the University of Waterloo and Queen’s University, one team awarded a silver medal, Lethbridge Collegiate, and two teams awarded a bronze medal, University of Calgary and Lethbridge high school. In addition to medals 4 special awards were given out including best academic innovation to McMaster University, best entrepreneurship exploration and best scientific communication to University of British Columbia, and best collaboration to the University of Ottawa
With synthetic biology-based projects ranging from engineering various crops to developing software to help predict vaccine targets, the iGEM teams demonstrated a breadth of knowledge that can be readily applied to address imminent global and local issues, leaving all of the attendees nothing but impressed. Have a look below to see what each team worked on! More information including project presentations can be found at the cgem2020.ca website.
The Teams
McMaster: Built a mathematical model of a bacterial population carrying antibiotic resistance genes subjected to sustained antibiotic pressure due to the antisense oligonucleotide (ASO)-mediated silencing of antibiotic resistance genes! They also worked on validating the time to failure, frequency of specific and non-specific mutations that lead to resistance and explored clinical trials to better understand ASO cytotoxicity and patient adherence.
Guelph: CRISPR for Climate Resistance. They are working on controlling the expression of plant genes such as cold tolerance genes or drought resistance genes to enable the plant to survive in harsh conditions. Also, in an attempt to democratize science, they have designed an affordable shaking incubator and with further testing, intend to make this model available to other iGEM teams so they can build their own too.
Ottawa: Developing a solution to remediate plastic pollution in freshwater environments. By developing a bioreactor and utilizing a plastic degrading enzyme, PETase, water from wastewater treatment plants can be more thoroughly processed and plastic extraction can be improved. The broken down plastic could be recycled and used to make biogas or more plastic products.
Toronto: Generating more efficient plastic-degrading enzymes by combining rational design and machine learning. The team has proposed a bioreactor for textile recycling in Toronto, diverting them from landfills, by generating more stable and efficient variants of current plastic degrading enzymes, such as PETase, MHETase, and LLC, and integrating these into E. coli.
UBC: Designed VPRE (Viral Predictor for mRNA Evolution), a software tool that simulates evolution to predict genetic mutations in viruses. Applying this software to emerging viruses, the evolution of protein sequences can be predicted and can help inform pre-emptive vaccine development that targets conserved viral proteins.
Lethbridge Collegiate: Engineering potatoes to express antimicrobial peptides as a solution to problems concerning agriculture. Having potatoes express antimicrobial peptides effective against Fusarium fungi, would eliminate the issue of infections during potato storage. Another possibility is to express antimicrobial peptides with known health benefits to help boost consumers' immune systems, increasing public resilience in the event of a pandemic.
Calgary: Developed, OVIITA, a food-safe beta-carotene rich strain of yeast that is modified to secrete enzymes to increase beta-carotene production and to help combat poor vitamin absorption for the prevention of Vitamin A deficiency. This would empower communities to cultivate their own renewable source of vitamin A locally. The team has also developed the Randle cell, a portable Vitamin A deficiency diagnostic device.
Lethbridge High School: Designed tPectinACE, Targeting Pectin to Accelerate Compost Enzymatically, a synthetic system to accelerate compost degradation. The team aims to create a system that can be utilized in households and in large-scale composting facilities to help eliminate the methane gas produced from composting which contributes to climate change.
Queens: Developed a biosensor for the quantification of chronic kidney disease (CKD) biomarkers such as parathyroid hormone and fibroblast growth factor 23. The current monitoring method in Canada is through blood samples every 6 weeks and this time frame makes it difficult to provide patient-specific treatments. The biosensor would allow for frequent monitoring and early CKD detection, leading to better patient outcomes.
Waterloo: Designed REMINE, a column bioreactor with metal-binding proteins to remove toxic heavy metals from electronic manufacturing wastewater. This also allows for heavy metal recycling as they are very valuable. REMINE system can be customized to target specific metals, making it adaptable to the environment it is used in.
Best of luck to Queen’s, Waterloo, Lethbridge Collegiate and high school, and Calgary upcoming iGEM competition, we know you will make us all proud! And make sure to keep an eye out for Part II of our cGEM summary coming soon.